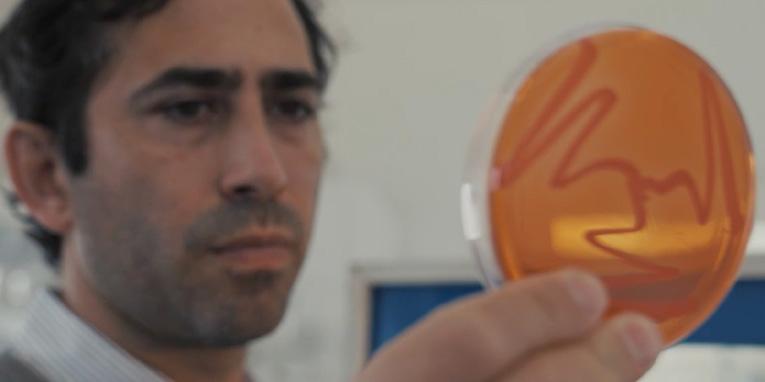
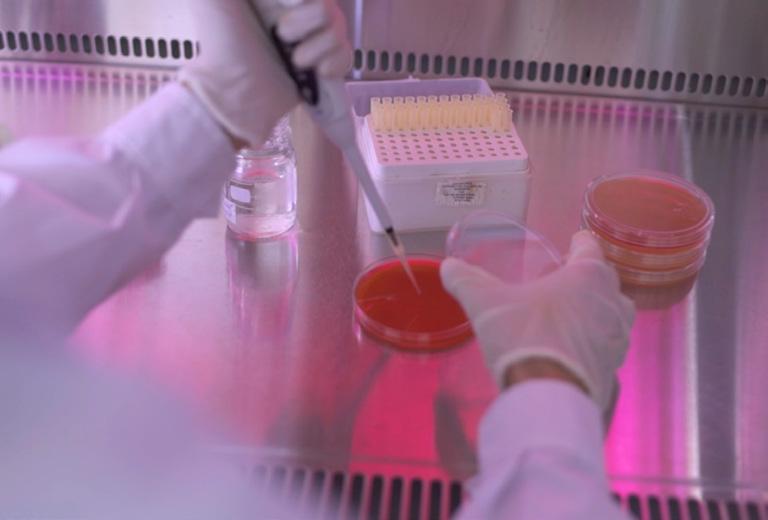

EDITORIAL
CALENDARIO AAPRESID
Nuestros aliados: el sorgo y el maíz Eventos del mes
NOTAS DESTACADAS

MANEJO DE PLAGAS
A controlar maíces guachos para combatir el achaparramiento del maíz

MANEJO DE PLAGAS
Una plaga disruptiva que nos desafía a volver a aprender

MANEJO DE PLAGAS
Refugios: el escudo del maíz Bt
106 60
66
04 134
SUMARIO 230
REVISTA AAPRESID 2
Cultivos con superpoderes microbianos: la revolución de la ingeniería de la rizosfera"
BIOECONOMÍA
Maíz argentino: entre la sequía y la chicharrita, un sector resiliente que busca superar obstáculos
MANEJO DE PLAGAS
A controlar maíces guachos para combatir el achaparramiento del maíz
Una plaga disruptiva que nos desafía a volver a aprender
Achaparramiento del maíz en contexto: entender para enfrentar mejor este desafío a los sistemas de producción
PRODUCCIONES ALTERNATIVAS
Bananas argentinas: una fruta tropical con sello nacional
GANADERÍA
6 principios básicos de la ganadería regenerativa
INSTITUCIONAL
Sistema Chacras Aapresid: 15 años nutriendo el campo con ‘materia gris’
MANEJO DE CULTIVOS
¿El año del sorgo? Secretos de un cultivo con soluciones del lote al mercado
Beauveria bassiana, una alternativa eficaz contra la chicharrita dentro de un manejo integrado
Brasil y la cigarrinha do milho: nueva variante africana y el futuro de los bioinsecticidas
Refugios: el escudo del maíz Bt
SD - SOCIO DESTACADO
El socio Aapresid que lleva 38 años sembrando futuro con raíces
10 24 50
CIENCIA
AGRO 42 60 66 80 88 96 106 118 110 126
Y
EDITORIAL Nuestros aliados: el sorgo y el maíz

El sorgo y el maíz son dos cereales conocidos y utilizados en todo el mundo. El sorgo tiene sus orígenes alrededor del año 8000 a.C., en las regiones tropicales y subtropicales de África oriental, mientras que el maíz fue cultivado por primera vez hace unos 10.000 años a.C. en México. La domesticación de estos cereales fue un hito muy importante que permitió a los grupos nómadas volverse sedentarios y su cultivo fue el sustento de los pueblos mesoamericanos.
En Argentina, la producción de maíz alcanzó un promedio de 53 millones de toneladas anuales en los últimos años. La provincia de Córdoba es la mayor productora del país, con aproximadamente 21,7 millones de toneladas, seguida por Buenos Aires y Santa Fe, con una superficie cultivada de 7,3 millones de hectáreas.
En cuanto al sorgo, la superficie sembrada en nuestro país es mucho menos representativa, con cerca de 900.000 hectáreas sembradas en los últimos años y una producción anual de alrededor de 3 millones de toneladas.
A nivel mundial, el sorgo es el cultivo que más toneladas aporta, con aproximadamente 800 millones de toneladas. Los principales productores son Estados Unidos y China, escoltados por Brasil, Argentina y otros países.
Estos dos cereales son de suma importancia en la cadena agroindustrial del país debido a sus múltiples usos. Desde la alimentación animal (ganadería, avicultura, porcinos, etc.) hasta la alimentación humana en sus diferentes formas, la producción de combustibles como bioetanol y biocombustibles sólidos, la generación de electricidad, etc.
El maíz ha experimentado un notable desarrollo tecnológico desde sus inicios hasta la actualidad, aumentando su producción por unidad de área año tras año. Este desarrollo se ha sustentado en gran medida en la tecnología de procesos, que resulta clave para cuidar el medioambiente e impulsar la producción.
REVISTA AAPRESID 4

Además del ingreso de divisas por exportación del grano, es importante considerar el aporte económico que estos dos cultivos generan en toda su cadena de valor, que incluye la venta de semillas, productos fitosanitarios, fertilizantes, transporte, maquinaria e industrialización, entre otros.
Estas dos especies son pilares fundamentales para la sostenibilidad de la siembra directa en amplias regiones de nuestro país. Su inclusión en la rotación tiene un gran impacto positivo gracias a su aporte de carbono al suelo, que contribuye a la generación de materia orgánica. Además, el rastrojo en la superficie protege el suelo contra la erosión hídrica y eólica. En la fracción subsuperficial del suelo, el sistema radicular de estas especies contribuye al mantenimiento de la salud física del suelo al formar macro y mesoporos.
Merece un párrafo aparte el gran aporte de estas gramíneas, conocidas como carbono 4, a la captura de CO2 de la atmósfera. A través de la fotosíntesis, transforman este CO2 en diferentes fuentes de energía -mencionadas anteriormente-, contribuyendo así a la mitigación del cambio climático.
Por otro lado, debemos mencionar a la plaga “estrella” que puso en jaque al cultivo de maíz en esta campaña: la chicharrita del maíz, o Dalbulus maidis. A pesar de su diminuto tamaño,
este insecto representa un gran riesgo para el cultivo, ya que es vector de virus y fitoplasmas que afectan gravemente al maíz cuando lo atacan en sus estadios vegetativos tempranos.
Esto imposibilita el traslado de fotoasimilados hacia los granos, que son la parte de mayor valor económico en este cultivo.
En diferentes medios de comunicación, ya se está alertando sobre las severas pérdidas que se están cuantificando y que se esperan para la campaña actual (2023-2024). Numerosos especialistas, incluidos entomólogos, fisiólogos e ingenieros, están trabajando arduamente para encontrar formas de manejo que permitan combatir esta plaga de manera efectiva.
Entre las estrategias que se están considerando, el cambio de cultivo de maíz por sorgo, girasol o soja es una de las más sólidas. De hecho se espera un aumento de la superficie sembrada con estos tres cultivos como reemplazo para la próxima campaña. Otras estrategias contemplan la modificación de la fecha de siembra del maíz, anticipándola, y no menos importante, una buena nutrición y un manejo adecuado del cultivo.
Ing. Agr. Mariano
Drincovich
MP 4288 CIAPC
Socio Aapresid Regional Vicuña Mackenna



STAFF

EDITOR RESPONSABLE
Marcelo Torres
Presidente de Aapresid
DIRECTORA ADJUNTA PROSPECTIVA
Paola Díaz
EDITOR EJECUTIVO
Rodrigo Rosso
REDACCIÓN Y EDICIÓN
Antonella Fiore
GESTIÓN DE CONTENIDO
María Eugenia Magnelli
CORRECCIÓN Y REDACCIÓN
Lucía Cuffia
DISEÑO Y MAQUETACIÓN
Daiana Fiorenza
Chiara Scola
GERENTE COORDINADOR
Tomás Coyos
PROGRAMA PROSPECTIVA
Rodrigo Rosso
Antonella Fiore
Lucía Morasso
Delfina Petrocelli
GENERACIÓN DE RECURSOS
Matías Troiano
Alejandro Fresneda
Carla Biasutti
Elisabeth Pereyra
SUBDIRECTORA ADJUNTA PROSPECTIVA
Carolina Meiller
COMUNICACIÓN INTERNACIONAL
Matilde Gobbo
Florencia Cappiello
Elina Ribot
Magalí Asencio
Agustina Vacchina
Delfina Sanchez
MARKETING
Lucía Ceccarelli
SISTEMA CHACRAS
Andrés Madias
Suyai Almirón
Magalí Gutierrez
Lina Bosaz
Ramiro Garfagnoli
Solene Mirá
RED DE MANEJO DE PLAGAS
Eugenia Niccia
Juan Cruz Tibaldi
Matías D´ortona
REGIONALES
Virginia Cerantola
Bruno De Marco
Joel Oene
SECRETARÍA
Karen Crumenauers
Mailén Saluzzio
Federico Ulrich
CERTIFICACIONES
Juan Pablo Costa
Rocío Belda
Eugenia Moreno
Myrna Masiá Rajkin
ADMINISTRACIÓN Y FINANZAS
Cristian Verna
Vanesa Távara
Dana Camelis
María Laura Torrisi
Mariana López
Daniela Moscatello
Samanta Salleras
Julieta Voltattorni
GESTIÓN DE PERSONAS
Macarena Vallejos
RELACIONES INSTITUCIONALES
Lucía Muñoz
PROYECTOS ESTRATÉGICOS
María Florencia Accame
María Florencia Moresco
1639 Piso
A Tel. 0341 426 0745/46
La publicación de opiniones personales vertidas por colaboradores y entrevistados no implica que sean necesariamente compartidas por la dirección de Aapresid. Queda prohibida la reproducción total o parcial de los contenidos sin autorización expresa del editor.
Dorrego
2 Of.
aapresid@aapresid.org.ar www.aapresid.org.ar
Cultivos con superpoderes microbianos: la revolución de la ingeniería de la rizosfera
Los cultivos enfrentan diversos estreses que limitan su crecimiento. La diversidad microbiana en la rizosfera mejora la inmunidad y la adquisición de nutrientes. La ingeniería del microbioma de la rizosfera optimiza estas funciones, lo que se traduce en una producción estable y de alto rendimiento.


Por:
Dr. Hugo Permingeat
Comité de Prospectiva Tecnológica de Aapresid
CIENCIA Y AGRO CIENCIA Y AGRO
10 REVISTA AAPRESID

El concepto de rizosfera fue propuesto por primera vez por Lorenz Hiltner en 1904. Este término se refiere a un microambiente del suelo que es complejo y altamente dinámico, influenciado directamente por las raíces de las plantas, y con características fisicoquímicas y biológicas únicas. La rizosfera es un nicho crítico para la interacción entre plantas, suelo y microorganismos. Las plantas coevolucionaron con los microorganismos y dependen de ellos para la adquisición de nutrientes y la protección contra diversos estreses bióticos y abióticos.
Las limitaciones ambientales, como el estrés abiótico debido a la sequía, la salinidad y la sodicidad del suelo, así como el estrés biótico causado por plagas y patógenos, plantean desafíos importantes para la producción agrícola, lo que resulta en una reducción del rendimiento de los cultivos y pérdidas de calidad. Diseñar y mantener un microbioma de rizosfera bien equilibrado, utilizando herramientas adecuadas, es una estrategia prometedora para mejorar la eficiencia de la absorción de nutrientes y fortalecer la resis-
tencia contra plagas y patógenos, lo cual es crucial para la agricultura sostenible moderna (Chen y col., 2023).
En este contexto, se define la ingeniería de la rizosfera como la manipulación dirigida de plantas, suelo, microorganismos y manejo agrícola para modificar los procesos de la rizosfera con fines específicos. Así, la ingeniería de la rizosfera se está convirtiendo cada vez más en una estrategia clave para abordar varios desafíos críticos. Esto incluye: mejorar la productividad y la sostenibilidad de los agroecosistemas; mitigar el cambio climático (por ejemplo, aumentando el secuestro de C en el suelo); superar el estrés biótico y abiótico (por ejemplo, pH alto o bajo, salinidad elevada, sequía) en la producción de cultivos; mejorar las propiedades del suelo; y aumentar la eficiencia en el uso de fertilizantes y otros recursos.
Muchos estudios previos se han enfocado en los efectos del manejo de la rizosfera para mejorar la productividad de las plantas. Otros objetivos de la gestión de la rizosfera son igualmente importantes, especialmente si se tiene en cuenta la gestión sostenible de los ecosistemas y la mitigación del cambio climático (Wang y Kuzyakov, 2024).
La ingeniería de la rizosfera puede abordarse desde diferentes enfoques. Yang y col. (2023) revisan estas alternativas, basadas tanto en el uso de herramientas tradicionales como en herramientas emergentes. Las vías tradicionales incluyen una ingeniería indirecta del microbioma utilizando prácticas agrícolas conocidas, como el uso de cultivos intercalados, la rotación de cultivos y los cultivos de servicios, que promueven mejoras en las propiedades físicas y químicas de los suelos mediante la formación de agregados, el aumento del contenido de materia orgánica y la disponibilidad de nutrientes. Esto también genera un círculo virtuoso en las interacciones entre plantas y microbiomas para mejorar las propiedades bióticas del suelo.

La adición de enmiendas para alterar el ambiente de la rizosfera es otra vía indirecta tradicional, que incluye una serie de insumos or-
REVISTA AAPRESID 12
gánicos, tales como los residuos de cultivos, los abonos verdes, el compost y algunos insumos inorgánicos. Estos aportes mejoran las propiedades fisicoquímicas del suelo y proporcionan a los microorganismos una fuente de energía que conduce a mejorar la salud del suelo. Por ejemplo, el agregado de estiércol mejora la actividad microbiana y la diversidad en el suelo de la rizosfera, lo que conduce a un aumento en los exudados de raíces liberados debido a una ma yor actividad biológica en la rizosfera. La adición de compost puede ayudar a las plantas a afron tar el estrés abiótico y biótico.









Por su parte, una ingeniería directa de las vías tradicionales incluye el uso de inoculantes y fungicidas. Las conocidas bacterias promotoras del crecimiento de plantas (PGPB, por sus siglas en inglés) utilizadas como inoculantes pueden inducir un cambio microbiano hacia comunidades más saludables, que ya se han utilizado para controlar algunas enfermedades transmitidas por el suelo actuando como agentes de biocontrol.
Existen otras enmiendas que se utilizan para los tratamientos del suelo, como los fumigantes y fungicidas. Estos enfoques a menudo pueden alterar directamente el microbioma del suelo y crear una oportunidad para que se establezcan nuevas comunidades microbianas en la planta o el suelo al suprimir el crecimiento de patógenos y/o introducir microorganismos beneficiosos.
Actualmente, los fumigantes seguidos de biofertilizantes pueden controlar eficazmente las enfermedades transmitidas por el suelo y, al mismo tiempo, preservar la biodiversidad microbiana en los suelos (Yang y col., 2023).
Estos mismos autores también sugieren varios enfoques novedosos para diseñar el microbioma de la rizosfera y así mejorar la eficacia microbiana y optimizar las interacciones beneficiosas entre la planta y el microbioma. Estos incluyen consorcios microbianos "a la car-

REVISTA AAPRESID 14

ta" (consorcios microbianos sintéticos, inóculo seleccionado mediante ingeniería de microbiomas mediada por el huésped), prebióticos elaborados a partir de exudados de raíces de plantas específicas y mejoramiento de cultivos para mejorar la interacción beneficiosa del microbioma (Yang y col., 2023).
Los consorcios microbianos sintéticos (SynCom) se refieren a un conjunto comunitario simplificado de un número limitado de cepas que contienen múltiples funciones del microbioma natural. Los SynCom, basados en una metodología de biología sintética, pueden remodelar la estructura y función del microbioma de la rizosfera. Un excelente consorcio microbiano tiene una mayor capacidad para soportar fluctuaciones ambientales que una cepa individual y, simultáneamente, proporcionar una amplia gama de funciones promotoras del crecimiento vegetal a la planta huésped.
Estos SynCom tienen la característica de ser diseñados y construidos para ambientes específicos. Los pasos involucrados en la construcción de un SynCom deseado incluyen la selección de los microorganismos miembros, la obtención y el cultivo de los microorganismos centrales, la optimización de las interacciones

microbianas y la evaluación de la eficacia. Las combinaciones microbianas centrales seleccionadas en función del enfoque de machine-learning constituyen un desafío importante en la ingeniería de un SynCom, particularmente para mantener su estabilidad a largo plazo en competencia con la comunidad nativa y en condiciones adversas.
Otro aspecto es su aplicación; por ejemplo, se ha demostrado que el recubrimiento de semillas promueve la colonización microbiana y, por lo tanto, podría mejorar la eficiencia de SynCom en comparación con la aplicación al suelo, debido a sus efectos prioritarios. Es importante señalar que SynCom solo incluye microorganismos fácilmente cultivables, lo que da como resultado una estructura más simple y con menos funciones en comparación con los microbiomas naturales. Esto hace que sea cru-
cial encontrar medios de cultivo adecuados para explorar y cultivar nuevos microbiomas con características beneficiosas. Para desarrollar un SynCom estable y eficaz para la agricultura, se necesitarán enfoques novedosos y el uso de diferentes dimensiones de datos ómicos, como datos genómicos y de perfiles microbianos (Yang y col., 2023).
Se ha demostrado que el recubrimiento de semillas promueve la colonización microbiana y, por lo tanto, podría mejorar la eficiencia de SynCom en comparación con la aplicación al suelo

REVISTA AAPRESID 16
La ingeniería de microbiomas mediada por el huésped (HMME, por sus siglas en inglés) es una estrategia que utiliza la planta huésped para seleccionar microorganismos de interacción indirectamente bajo ciertas presiones, lo que conduce a un mejor crecimiento y aptitud ambiental de la planta. HMME también podría mejorar la adaptación de las plantas a diferentes tipos de estrés. Este enfoque HMME facilita que la descendencia de la planta y el microbioma se reconozcan entre sí en nuevos entornos porque la descendencia recibe un subconjunto de microbiota transferida de sus padres. Esta selección "evolutiva" mejora la capacidad de supervivencia y la eficacia de SynCom como inoculante aplicado a la planta, lo que conduce a una comunidad microbiana de la rizosfera estable y eficiente.

Además, el enfoque HMME se basa en el nivel del ecosistema, en lugar de aislamientos individuales, y tiene el potencial de resolver problemas biológicos complejos desde una perspectiva sistémica. Las investigaciones futuras deberían centrarse en obtener comunidades microbianas inducidas por estrés a través de la vía HMME y comprender los mecanismos de coadaptación/coevolución entre plantas y comunidades microbianas. Para estabilizar y mantener la actividad de inoculación a lo largo del tiempo, se necesitan enfoques adicionales de ingeniería de microbiomas para la agricultura sostenible. Recientemente, se han propuesto como estrategias alternativas de ingeniería de microbiomas el uso de prebióticos para atraer y mantener microbios y el mejoramiento de cultivos para lograr interacciones beneficiosas con el microbioma (Yang y col., 2023).
Las enmiendas de exudados de raíces como prebióticos para atraer y mantener microbiomas beneficiosos en la rizosfera es otra estrategia novedosa bajo análisis. Se cree que los prebióticos (como los metabolitos especiales de las plantas) pueden dar forma a las comuni-
dades microbianas al estimular el crecimiento o la actividad de microbios específicos. Esto, a su vez, puede mejorar la salud general de la planta. Los metabolitos de origen vegetal se han utilizado como agentes terapéuticos para alterar la composición y función microbiana, reduciendo las especies dañinas y mejorando la homeostasis de la comunidad microbiana. Se sugiere que los exudados de raíces liberados en la rizosfera son moléculas de señal importantes para los microorganismos. Actualmente, se ha descubierto que algunos componentes del exudado de raíces actúan como prebióticos naturales, enriqueciendo selectivamente especies microbianas específicas o desencadenando actividades microbianas que benefician a la planta huésped (Yang y col., 2023).
El microbioma de la rizosfera está influenciado por las propiedades físicas y químicas del entorno de la rizosfera, lo que a su vez afecta la aptitud de la planta.
También hay una estrategia desde el mejoramiento de cultivos para lograr una interacción beneficiosa del microbioma. Las plantas y los microorganismos han evolucionado juntos y cada uno se afecta entre sí de diversas maneras. El microbioma de la rizosfera está influenciado por las propiedades físicas y químicas del entorno de la rizosfera, lo que a su vez afecta la aptitud de la planta. Diferencias genéticas vegetales pueden dar lugar a diferentes patrones de exudación de raíces, que influyen en la composición y función de los microbiomas de la planta y del suelo. El mejoramiento de cultivos que per-
REVISTA AAPRESID 18

siguen interacciones beneficiosas del microbioma implica la utilización de genotipos (cultivares) de plantas disponibles para atraer comunidades microbianas beneficiosas a la rizosfera. Al cultivar una planta con rasgos beneficiosos relacionados con el microbioma se puede establecer una interacción natural y beneficiosa entre las plantas y el microbioma, y se pueden abordar los problemas de colonización ineficaz en la rizosfera. Este enfoque basado en el genotipo para la regulación del microbioma tiene el potencial de proporcionar un amplio espectro de servicios ecosistémicos, incluida la promoción del crecimiento de las plantas y la tolerancia al estrés abiótico (Yang y col., 2023).
Otro enfoque de la ingeniería de la rizosfera es el que proponen Wang y Kuzyakov (2024), que está vinculado al aumento del secuestro de C en el suelo. En el análisis plantean que las plantas, los microorganismos, los suelos y sus interacciones pueden diseñarse mediante enfoques agrícolas, físicos, químicos y biológicos individuales o combinados. Todos estos enfoques se centran en acumular y estabilizar C en el suelo, ya sea directa o indirectamente: (i) aumentando los aportes de C derivado de las raíces, (ii) aumentando la producción de biomasa y necromasa microbiana, y (iii) mejorando la estabilización del C en el suelo.
Los más prometedores y adecuados para su aplicación son la selección de plantas (enfoque de la genética agrícola), la fertilización (enfoque de agricultura química), el manejo del microbioma (enfoque biológico) y la edición
Otro enfoque de la ingeniería de la rizosfera está vinculado al aumento del secuestro de C en el suelo.
REVISTA AAPRESID 20

250 charlas

12 ejes temáticos

300 disertantes
7, 8 y 9 de agosto de 2024
La Rural, Predio Ferial de Buenos Aires Ciudad Autónoma de Buenos Aires, Argentina
ventas@exponenciar.com.ar | comercial: +54 9 11 5844-2945 | +54 9 341 601-6111 APOYAN ORGANIZAN
del genoma junto con la regulación de la expresión genética (enfoques genómicos). Los autores plantean que se deben considerar las propiedades fisicoquímicas del suelo y las condiciones climáticas para diseñar y aplicar todos estos enfoques. La tasa estimada de secuestro de C puede llegar a 103 kg C ha–1 año–1, dependiendo del enfoque de ingeniería. Por lo tanto, la ingeniería de la rizosfera puede servir como una estrategia prometedora para mitigar el calentamiento global.
En las próximas décadas será posible realizar modificaciones sistemáticas de la zona de raíces para satisfacer las necesidades de la agricultura sostenible. Al mejorar la interacción y cooperación entre microorganismos beneficiosos y microorganismos autóctonos, se
espera diseñar y construir un microbioma de rizosfera potente, estable y funcionalmente diverso. Es de esperar los resultados de más investigaciones que integren tecnologías emergentes como la biología sintética, la edición génica y los análisis multiómicos, entre otros, que contribuyan a la comprensión profunda y a la aplicación plena de las interacciones positivas entre plantas y microorganismos, y así desarrollar el llamado "microbioma impulsado" en los sistemas de cultivo (Chen y col., 2023).
La ingeniería de la rizosfera ofrece una solución innovadora para impulsar la sostenibilidad y eficiencia en la agricultura. Al enfocarse en el ecosistema microbiano que rodea las raíces de las plantas, esta estrategia promueve una mayor absorción de nutrientes y agua, redu-

REVISTA AAPRESID 22
ciendo así la necesidad de fertilizantes y riego excesivo. Además, al fortalecer la salud de las plantas, se incrementa su resistencia a enfermedades y plagas, disminuyendo la dependencia de pesticidas. La ingeniería de la rizosfera no solo ofrece mejorar la productividad de los cultivos, sino que también reduce el impacto ambiental al minimizar la lixiviación de químicos y la erosión del suelo. En resumen, la ingeniería de la rizosfera representa un enfoque holístico y sostenible para cultivar alimentos de manera eficiente y responsable.
REFERENCIAS
Consulte las referencias ingresando a www.aapresid.org.ar/blog/revista-aapresid-n-230
Instituciones que nos acompañan















Sistema Chacras Aapresid: 15 años nutriendo el campo con ‘materia gris’
En las voces de sus protagonistas, repasamos la historia de este Programa que lleva la ciencia al lote para encontrar soluciones sustentables a la medida de cada realidad productiva.
Los nuevos conocimientos para el agro suelen venir desde el ámbito académico-científico o incluso desde las propias empresas de tecnología, donde el investigador plantea una hipótesis y la pone a prueba con el método científico. Sin embargo, ese conocimiento no siempre satisface directamente las demandas que existen a campo. Y ese “a campo”, que parece tan general, incluye en realidad un mosaico de realidades y necesidades que varía de un ambiente a otro. También incluye la cultura, la forma de entender y hacer las cosas, el conocimiento y la experiencia de cada productor.
El director Académico de Sistema Chacras Aapresid, Rodolfo Gil, explica que “la sustenta-

bilidad se construye de manera colectiva y que, en ese sentido, entender las contribuciones que la gente local puede hacer para resolver sus propios problemas es clave para el desarrollo sostenible. Cuando ese saber práctico, que de alguna manera pasó la prueba del tiempo, se junta con el conocimiento científico, se genera una sinergia que permite obtener soluciones rápidas y de calidad”.
Sistema Chacras es el Programa de la Aapresid que, desde hace 15 años, reúne a científicos de instituciones como INTA, productores y empresas sobre el terreno para buscar soluciones a desafíos locales a través de la innovación colaborativa.
INSTITUCIONAL REVISTA AAPRESID 24



La idea fundacional
En 1983, el joven agrónomo Rodolfo Gil ingresó en la EEA de INTA en Manfredi, donde tomó contacto con dos pasiones: el suelo y el extensionismo. Sobre el primero, relata: “Me interesaba indagar sobre cómo podíamos producir sin dañarlo. En ese entonces habría en el país unas 4.000 hectáreas bajo Siembra Directa (SD), con experiencias muy aisladas. Mi primer ensayo con SD fue en soja sobre trigo, y fue impactante ver crecer a las plantitas de soja entre los rastrojos de trigo, sobre todo porque más que un cambio tecnológico, significaba un cambio cultural Era derribar una cultura ancestral que era parte de la Humanidad: la labranza”.



REVISTA AAPRESID 26
Primer ensayo de Siembra Directa en 1983 de Rodolfo Gil.

Luego de realizar un posgrado en “Ciencias del suelo” en la UBA, Rodo volvió a Córdoba como jefe de Agencia de la EEA Río Tercero, una zona profundamente afectada por la erosión y con una fuerte cultura manicera. Fue ahí donde unió su interés por la conservación del suelo con el extensionismo y la docencia -tarea que según él mismo no dejó de ejercer nunca-, poniendo en práctica un proyecto de “conservación de suelos y aguas”. El mismo consistía en asociar a diversos actores agrícolas de la región bajo un enfoque participativo, donde los productores fueran parte de los procesos de definición y resolución de los problemas que enfrentaban.
“Yo estaba convencido de que las respuestas tenían que salir de ellos, que tenían que ser protagonistas de su propio desarrollo”. Pero además, Rodo creía que convertir a los productores y sus campos en figuras activas de producción y transmisión de conocimientos era clave para multiplicar las capacidades de los técnicos de INTA en cada territorio.
Fue así como en los años siguientes, trabajó en desarrollar estas ‘unidades de desarrollo agrícola’, basadas en pequeños grupos locales y en interacciones personalizadas entre técnicos


especializados y los productores para encontrar soluciones a las problemáticas identificadas. Dichas unidades debían, además, contar con una estructura flexible, ágil y descentralizada, de manera de no quedar atadas al funcionamiento u objetivos de investigación de las Instituciones matrices.
En 2007, tomó contacto con productores de Aapresid que en ese entonces buscaban desarrollar cultivos extensivos como soja, maíz y trigo bajo SD en Chaco. Al ser una región sin esa historia agrícola, estos pioneros se encon-

traron con un gran vacío de conocimiento y de referentes técnicos a nivel local.
“En ese grupo de pioneros estaba Rogelio Fogante, un referente de la ciencia y la producción, y fue con él con quien instalamos en la zona una de estas unidades de desarrollo”, recuerda Rodo. Con los conocimientos de este último como técnico de INTA, comenzó la experimentación a través de ensayos en los mismos lotes de producción para testear y ajustar parámetros técnicos.

Rogelio Fogante (Aapresid) y Rodolfo Gil (INTA), fueron motores clave en la creación de “Sistema Chacras”, convencidos del potencial que tenía la sinergia entre productores y científicos para encontrar respuestas a los problemas locales.
REVISTA AAPRESID 28
“Rogelio entendía como yo la importancia de estas ‘unidades de desarrollo’, donde la figura central tenía que ser el productor con su necesidad, acompañado desde la ciencia para encontrar soluciones efectivas en el menor tiempo posible. En estas unidades, el ensayo no sería del investigador, sino del que tiene el problema, facilitando la generación de conocimiento práctico”.
Esta metodología sería el camino para apartarse de los “promedios” y empezar a pensar en variabilidad ambiental; así como de las “recetas generalizadas” para empezar a pensar en estrategias de manejo ajustadas a cada ambiente y sistema de producción.
Juntos decidieron “institucionalizar” la idea, llevándola ante directivos de Aapresid y promoviendo la alianza con INTA. “Convencer a INTA de salirse del marco de sus estaciones experimentales para conducir ensayos en los campos de los productores fue todo un desafío”, recuerda. Fue en 2008 que se formalizó esta alianza, con el acuerdo entre Aapresid y el

INTA que dio origen a lo que hoy conocemos como el Programa “Sistema Chacras”.
“Durante los primeros años, los desafíos del programa fueron tres: un presupuesto reducido, ‘aguantar’ algún tiempo hasta generar resultados que contagien a nuevos productores y se formen nuevas Chacras, y acompañar ese crecimiento con un nivel de profesionalismo y estructura poco conocidos y difíciles de copiar”, recuerda Tomás Coyos, ex gerente del Programa y hoy coordinador General de Aapresid. En este sentido, las primeras Chacras que se establecieron fueron, de alguna manera, la punta de lanza para que el programa crezca y se fortalezca.
Metalfor, la Fertilizadora oficial de Aapresid Conocé más en www.metalfor.com.ar
El caso Pergamino-Colón y el cierre de brechas productivas
La Chacra Pergamino-Colón fue una de las pioneras del Programa. “El disparador que dio origen a la Chacra fue una visita en 2009 de un especialista de Estados Unidos, quien nos planteó que con los suelos y las precipitaciones que tenemos, la zona ofrecía un potencial productivo que no estaba siendo explorado. Hasta el momento el único doble cultivo que se hacía era trigo/soja”, explica Cesar Belloso, miembro de la Chacra.

Los primeros pasos de la Chacra Pergamino.

REVISTA AAPRESID 30

Chacra Pergamino-Colón.

Así, la Chacra nació buscando oportunidades de aumentar el número y diversidad de cultivos de las rotaciones. Los sitios de estudio iban de rotaciones típicas de la zona hasta coberturas permanentes con praderas de gramíneas y alfalfa.
En el medio, una gama de cultivos de renta y de servicios, en distinta combinación e intensidad.
“Hacernos cargo del proyecto era de alguna manera buscar las respuestas que no estábamos recibiendo del sector privado ni de organismos del Estado, que si bien tenía trabajos en esa línea, estaban fuera de la zona”, explica Belloso.
Este ‘hacerse cargo’ también fue en lo económico: “Si bien hubo empresas que nos acompañaron parcialmente, el trabajo de esos primeros años fue sostenido con los aportes económicos de los productores de la Regional”, agrega.
Dado que no sólo se buscaba generar información local sobre el impacto de la intensificación y diversificación de rotaciones en los rindes y márgenes brutos, sino también en la eficiencia en el uso de recursos, en la salud del suelo y del ecosistema, la Chacra se asoció con especialistas en biología de suelos, en análisis de
impacto ambiental y en emisiones GEI de la UNQ, la UNRC e INTA.
La Chacra generó información relevante para la zona y fue pionera en varios temas. No sólo se comprobó que era posible aumentar el número de cultivos/año con impactos positivos en rindes y márgenes brutos, sino que también se logró avanzar en el conocimiento sobre cómo el manejo productivo modela la biología de los suelos, y cómo esta última impacta en la salud del agroecosistema regulando procesos como la captura de carbono, los ciclos de nutrientes y agua, entre otros.

Otra pionera fue la Chacra Bandera, que surgió en 2012 frente a la problemática de malezas resistentes. “No sólo faltaba conocimiento sobre el manejo de malezas en la zona, sino también sobre las propias malezas”, recuerda Pablo Lopez Anido, miembro de la Chacra.
La iniciativa se apoyó en especialistas y empresas de tecnologías, y comenzó con ensayos para el control de malezas. “Pero rápidamente fue evolucionando hacia un enfoque más integral, generando información de valor para la zona en temas como biología de malezas, uso de residuales y de cultivos de servicios", comenta Pablo.
Ese conocimiento se pone a disposición en cada taller de intercambio, ensayo y recorrida, y es la base de la formación de los técnicos responsables de cada proyecto. “Estos profesionales capacitados en la Chacra hoy trabajan en la zona, mejorando el panorama técnico local”, cierra el productor.
“Que un productor trabaje en investigación y desarrollo es interesante porque lo obliga a pensar, a hacerse preguntas, a buscar respuestas a medida. Es muy difícil que esto se genere desde otros sectores”, explica el miembro de esta Chacra, que también se financió con fondos de los mismos productores.
REVISTA AAPRESID 32
El caso Bandera y las malezas resistentes

Sistema Chacras: ¿cómo funciona hoy?
Con el paso de los años, la metodología de Chacras se fue estructurando y adquiriendo pautas básicas y premisas específicas de funcionamiento.
Una Chacra comienza cuando un grupo de productores plantea una necesidad común, que puede ser diversa: recuperar suelos degradados, cerrar brechas productivas, ajustar rotaciones en ambientes restrictivos, agregar valor, entre otras.
“Guiados por un Responsable técnico de desarrollo (RTD), se generan talleres para priorizar objetivos y líneas de trabajo que los productores abordarán sobre el terreno junto a especialistas de instituciones como INTA y Universidades, y empresas, a lo largo de 3 años y

liderados por una Coordinación Técnica Zonal y un equipo de expertos”, explica Andres Madias, actual gerente del Programa. Cuando se alcanzan los objetivos propuestos, puede iniciar un nuevo ciclo si se decide avanzar sobre nuevos interrogantes.
Todo proyecto que se inicia debe cumplir con dos premisas fundamentales. La primera: el ‘protagonismo horizontal’. “El productor no está esperando que la Ciencia le lleve respuestas, sino que sale a buscarlas, formando, de alguna forma, su propia área de I+D. Esto hace que tenga un mayor involucramiento y se sienta parte del proceso, lo que facilita la adopción de las soluciones generadas”, explica Madías.
Chacra Bandera.
Esta horizontalidad en la generación del conocimiento busca apartarse de los métodos de aprendizaje tradicionales del tipo “pedagógicos” o conductuales, donde hay una figura que enseña el camino y dice lo que hay que hacer. “El productor no es caprichoso en lo que hace; tiene evidencia práctica de lo que funciona y lo que no. Tiene cultura, intereses y objetivos de vida propios. Por tanto, más que enseñarle la respuesta a sus problemas, necesita que se le acompañe en la búsqueda de soluciones. Esta modalidad genera sinergia a nivel de grupos de personas porque se capitalizan capacidades, experiencias e ideas individuales”, explica Rodo.
En esta dinámica, el especialista o “científico” es un catalizador, desempeñando el doble rol de investigador y extensionista. Cristian Álvarez, investigador de INTA y experto de la Chacra América, explica que “a diferencia de la investigación básica, el científico de una Chacra trata de responder a cuestiones que ve el pro-


ductor. Así, la investigación se transforma en una herramienta más sensible, porque el productor está viendo directamente su respuesta a campo. Esto permite complementar la ciencia básica y la aplicada”.
La segunda premisa que debe cumplir una Chara es el ‘aprender produciendo’. “Cuando aprendemos ‘haciendo’, el aprendizaje es más efectivo. “Una de las cosas más lindas de la metodología Chacras es que no sólo se avanza sobre los espacios de incertidumbre, es decir, sobre ‘aquello que sabíamos que no sabíamos’, sino que se se descubren los espacios de ceguera, es decir, ‘aquello que no sabíamos que desconocíamos’. Y eso es buenísimo porque alimenta la mejora continua, sobre todo si en el camino nos equivocamos”, explica Rodo.
A estas dos premisas se podría sumar una tercera: la descentralización. La autonomía de cada Chacra es clave para que desarrolle sus propias potencialidades y especificidades. Pero sobre todo, para que lleve la impronta de


REVISTA AAPRESID 34

las personas y empresas que la integran, quienes conocen los problemas y la cultura de la zona, y quienes viven y sienten los problemas identificados. “Esta es una condición clave para impulsar el deseo de apropiarse de la generación de conocimientos”, explica Rodo.
El Responsable Técnico de Desarrollo (RTD) coordina el día a día de la Chacra y sus líneas de trabajo, tomando la temática a estudiar como eje de su tesis de posgrado.

Para Leandro Ventroni, ex gerente de Sistema Chacras, la formación de recursos humanos es otro de los puntos fuertes del Programa. “El paso por Chacras es una ‘residencia agronómica’ que nos prepara para entender cómo construir sistemas de producción sustentables para diferentes regiones agroecológicas.”
Alejo Ruiz fue RTD en la Chacra Justiniano
Posse, y rescata que su paso por Chacras le dio herramientas para asumir un rol tan importante como el agronómico, que es el de liderar personas. “Aprender a escuchar, a conciliar, a entender que son personas las que están detrás de cada dato técnico, con su idiosincrasia, su experiencia previa y personalidad”. Esto es algo en que los agrónomos no suelen formarse.

15 años después
A lo largo de 15 años, el Programa generó cerca de 20 Chacras, de las cuales 11 están hoy activas, en zonas que van desde Catamarca hasta la Patagonia, y con objetivos muy diversos.
El caso VINPA y cómo producir en el desierto
La Chacra Valles Irrigados Norpatagónicos (VINPA) surgió en 2012 a partir de un grupo de productores de Aapresid que querían probar si era posible hacer agricultura en campos de la zona, teniendo en cuenta que se trata de un
área casi desértica, con solo 200 mm anuales, suelos heterogéneos, poco desarrollados y con presencia de sales, que tradicionalmente podían soportar 1 vaca de cría cada 20 hectáreas.

¿Por qué alguien querría producir allí? Las condiciones de temperatura y radiación son de las mejores del país, aptas para producir casi cualquier cultivo. Pero para lograrlo había dos grandes desafíos.
El primero: aprovisionarse de agua de riego. En este sentido, el Rio Negro sería el gran aliado. Actualmente, vuelca al mar gran cantidad de excedentes sin que nadie lo aproveche en el trayecto. Pero los costos de extracción eran elevados, por lo que había que lograr rendi-

Regando sus suelos con las aguas del Rio Negro, la Chacra VINPA busca transformar una zona desértica en un polo productivo con rindes récord.
mientos que pudieran cubrirlos, manteniéndose siempre en un marco de sustentabilidad.
Así, el segundo gran desafío era llenar el vacío de conocimiento acerca de estrategias de manejo de suelos, riego y cultivos en una zona con nula historia en producción agrícola extensiva. De la mano de INTA se trabajó en generar información sobre manejo de los sistemas agrícolas bajo riego, posibles cultivos y formas de mejorar los suelos de la región, analizando
36 REVISTA AAPRESID
también el impacto de estos modelos de producción sobre parámetros de salud del suelo.
“La clave estaba en saber colonizar el suelo para que se genere cobertura. Luego, aprender a regar bien: entender cuánta agua va a demandar el cultivo -teniendo en cuenta que el viento y la temperatura de la zona ponen a las plantas a transpirar-, y cómo manejar la lámina
y frecuencia de riego para ser lo más eficientes en el manejo de un recurso tan costoso y sin afectar los rendimientos”, enumera Magalí Gutierrez, por aquel entonces Responsable Técnica de Desarrollo de la Chacra.
Por último, se hizo el ajuste fino de cultivos, posicionándose en la ventana de siembra que hay en la región, que es más corta que en zona núcleo.

Se ensayó trigo, cultivos de servicios (en especial vicia), maíz y soja. Y los resultados fueron llegando: trigos de 10.000 kilos/ha, maíces de 15.000 a 17.000 kilos/ha y sojas de 6.000 kg/ha, rindes no solo altos sino también muy estables.

Hoy la Chacra va por un nuevo ciclo con nuevos objetivos: profundizar aspectos del funcionamiento de los suelos, ajustar rotaciones para lograr un manejo eficiente de residuos de cosecha e integración con ganadería, apuntando a modelos productivos adecuados para la región.
El entramado de Chacras cubre cerca de 400.000 hectáreas, más de 150 productores y asesores, una sólida red institucional de la mano de INTA y más de 10 Universidades, el Ministerio de Agricultura de la provincia de Córdoba y más de 60 empresas del sector.
En los últimos años, el programa desarrolló el concepto de “Redes Temáticas”, una variante de las Chacras que busca llevar conocimiento en temas de interés para una región: cultivos de servicios, nutrición de cultivos, insumos biológicos, etc.

Hoy en día, Sistema Chacras es mucho más que un programa de Aapresid; es una condición necesaria para la innovación y un pilar fundamental de los sistemas productivos sustentables que promueve la institución, tan importante como la SD, la construcción de paisajes vivos y diversos, y el manejo ecológico de plagas y nutrientes.



REVISTA AAPRESID 38
‘El
placer del saber’

Aristóteles decía que la tendencia hacia la sabiduría es intrínseca de todo ser humano y que el deseo de saber fue y es una necesidad humana para sobrevivir, organizarse y consolidarse como tal. Hoy en día, el planeta nos desafía a producir más sin deteriorar los recursos. Adoptando la frase del filósofo, Rodo explica que “el cuidado del suelo es condición fundamental para lograr ese desafío, pero no la única. El primer paso quizá surja más del sentimiento que del conocimiento, del placer de saber”.
“Creo que esa satisfacción que genera la propia sabiduría será clave para que la responsabilidad ambiental deje de ser un compromiso de buena voluntad y se convierta en un rasgo



cultural, donde la ética, el respeto por el suelo y los recursos naturales se constituyan en valores insustituibles”.
“Ese camino sólo puede construirse con educación y concientización, no sólo de los productores y consumidores, sino también de aquellos que tienen a cargo la ardua tarea de generar conocimientos y transferirlos. A ellos debemos contagiarles el sentimiento de placer de aplicar y difundir prácticas sustentables”.
También destaca que es clave adaptar la formación de los futuros profesionales para que pongan énfasis en la estrategia para captar información que tenga significado dentro del contexto en el que se va a usar. Solo así la información
se transforma en conocimiento y, finalmente, en aprendizaje. Un profesional de la agronomía aprenderá más rápido a desarrollar su capacidad de análisis y habilidad para intervenir si, desde su formación, se vincula con los problemas reales de los ambientes productivos.
“Nuestro país cuenta hoy con una excelente plataforma para actuar en ese sentido: las estaciones experimentales, institutos de investigación y agencias de extensión distribuidas en todo el país de la mano de INTA, las asociaciones de productores con fuerte llegada regional, las carreras de agronomía y posgrados relacionados; constituyen la principal materia prima para el desarrollo, que no es otra cosa que la ‘materia gris’, cierra Rodo.



REVISTA AAPRESID 40





Maíz argentino: entre la sequía y la chicharrita, un sector resiliente que busca superar obstáculos

El sector maicero argentino demuestra su resiliencia y capacidad de trabajo conjunto para enfrentar el problema del complejo del achaparramiento del maíz. La red nacional de monitoreo es un ejemplo de que la unión hace la fuerza. De cara a la nueva campaña, se repiensan estrategias y recomendaciones para que el sector siga creciendo.
Por: MAIZAR Asociación Maíz y Sorgo Argentino
BIOECONOMÍA
REVISTA AAPRESID 42
La campaña 2023/24 comenzó con una situación compleja para el sector, luego de tres años de severa sequía e incertidumbre por el año electoral, aunque con un pronóstico de buenas lluvias. El agua, aunque dispersa, llegó e impulsó una siembra récord de maíz de casi 9 millones de hectáreas, con una gran inversión

en manejo del cultivo, tecnología e insumos, en una muestra de la resiliencia que caracteriza al agro argentino. En las siembras tempranas, que rondan el 35% del total, se están consiguiendo excelentes resultados. Pero la que parecía la revancha del maíz se opacó.
Achaparramiento del maíz: el cisne negro
Casi a la par que avanzaba el 2024, las siembras tardías de maíz empezaron a verse cada vez más acechadas por un desafío inesperado: la chicharrita, o Dalbulus maidis, un insecto transmisor de enfermedades, especialmente del complejo del Achaparramiento del maíz.
Esta problemática endémica de zonas tropicales y subtropicales, como las del norte del país, se extendió inusualmente hacia latitudes más bajas, causando pérdidas de rendimiento que varían de leves a severas, dependiendo de la fecha de siembra. Los daños fueron enormes en amplias zonas del país: hasta el cierre de esta edición, a fines de mayo, se estima que la cosecha esperada de maíz se ha reducido alrededor de un 25%, casi 14 millones de toneladas, y aún se están evaluando los daños finales.

El año 2023 es el más cálido de la serie histórica, siendo 0.83°C superior respecto al período de referencia 1991-2020.
REVISTA AAPRESID 44
En este contexto, desde Maizar se inició un trabajo colaborativo entre los diversos actores de la cadena del cereal, incluyendo instituciones, investigadores, técnicos, productores y compañías, del sector público y privado, a fin de recopilar información detallada de esta situación y desarrollar estrategias de manejo para prevenir su recurrencia en futuras campañas.
La campaña 2023/24 de maíz se caracterizó por un amplio escalonamiento en las fechas de siembra debido a las precipitaciones dispares. Esto, sumado a un invierno benigno, provocó un aumento inusual de la población de esta plaga, especialmente en la región central del país, donde nadie lo esperaba.
Desde Maizar se inició un trabajo colaborativo entre los diversos actores de la cadena del cereal, a fin de recopilar información detallada de la problemática de Achaparramiento del maíz y desarrollar estrategias de manejo para prevenir su recurrencia en futuras campañas.

Se estima que se ha reducido la cosecha esperada de maíz en alrededor de un 25%, casi 14 millones de toneladas, a causa de Spiroplasma.
Red Nacional de Trampas de Monitoreo de Dalbulus maidis
En respuesta al problema del complejo del Achaparramiento del maíz, instituciones claves del sector agropecuario (AAPPCE, AAPRESID, CREA, EEAOC y MAIZAR) están desarrollando una red nacional de monitoreo con trampas cromáticas adhesivas, con el propósito de ob-
tener información sobre la dinámica poblacional y la infectividad de esta plaga en las diferentes regiones productoras de maíz del país, para ponerla a disposición de los distintos actores involucrados del sector. INTA se integrará con el propósito de colaborar con la red.
REVISTA AAPRESID 46
La red se compone de tres pilares fundamentales:
Red de trampas centinelas (principales): Estará conformada por 450 trampas distribuidas en cinco regiones: Noroeste Argentino (NOA), Noreste Argentino (NEA), Zona Centro, Zona Núcleo y Litoral.
Red de monitoreo de infectividad de individuos: En 45 de los sitios más representativos se colectará un total de 5.400 individuos adultos de Dalbulus maidis para analizar, mediante técnica molecular (PCR), la presencia del patógeno Corn Stunt Spiroplasma (CSS) y entender la fluctuación infectiva estacional de las distintas zonas agroecológicas.
Red de trampas voluntarias: Estará siempre abierta a la participación de cualquier persona, institución u organización que desee colaborar con el monitoreo.
Toda la información recopilada a través de esta Red Nacional de Trampas de Monitoreo estará disponible públicamente en forma libre y gratuita en una plataforma online. Además, se elaborarán reportes periódicos que serán distribuidos a todos los interesados. Esta información permitirá a los productores, investigadores, técnicos y autoridades conocer la dinámica de población de esta plaga y su infectividad, para ayudar a su manejo y a la protección del cultivo del maíz.
La plataforma online estará disponible con dicha información a partir de julio de 2024. El proyecto tendrá una duración inicial de tres años. Esta iniciativa ejemplifica la cooperación institucional necesaria para proteger el cultivo de maíz en Argentina, proporcionando información actualizada y regional, y permitiendo decisiones colectivas fundamentadas.


El Congreso Maizar como fuente de información
A raíz de la problemática impuesta por esta plaga, el Congreso Maizar 2024 debió ser repensado. El lema que habíamos pensado era “Liberemos el talento colectivo”, para poner el acento en lo mucho que la cadena maicera tiene para recorrer en materia de agregación de valor, desarrollo regional, arraigo, sostenibilidad, modelos de negocios y otros aspectos. Queríamos abordarlo desde una perspectiva múltiple, considerando cada uno de los ámbitos que componen estas redes de valor: desde las semillas, los suelos, los insumos y el agua, hasta la conversión en proteínas animales, la bioenergía y los biomateriales, pasando por los marcos regulatorios, los avances tecnológicos, el contexto internacional, las cuestiones de infraestructura, los temas de impacto ambiental y las novedades tecnológicas.
Pero la irrupción de la chicharrita y el Spiroplasma también nos planteó liberar el talento colectivo, justamente para encontrar solución a este tema. Con gran satisfacción, pudimos convocar a las principales instituciones del sector público que, sin burocracias ni dilaciones, se pusieron a trabajar en el tema y conformaron un panel. Además, integramos otro panel con expertos de cada una de las empresas semilleras que, lejos de competir, sumaban conocimientos y compartían recomendaciones para cada zona, explicando por qué este problema creció tanto y qué prácticas de manejo lo van a controlar.
Allí quedó claro que el año pasado se dio una tormenta perfecta, que encontró lotes de maíz abandonados por la sequía previa, que ofrecieron refugio y alimento a la plaga; el invierno más cálido desde 1961, que permitió la supervivencia de muchísimas poblaciones; siembras escalonadas y puentes verdes; la ausencia de conocimiento y,
REVISTA AAPRESID 48

en consecuencia, de prácticas de manejo; y la falta de fitosanitarios y genética apropiada para una situación de estas características.
A la vez, los expertos compartieron distintas recomendaciones producto de lo aprendido para cada etapa del cultivo: barbecho, siembra, cultivo y poscosecha, en cada región. Sumados a la ayuda que el invierno más frío aportará este año, harán posible volver al cultivo en la mayoría de las regiones. Claramente, habrá que volver a hacer agronomía, pero ya está claro cómo se puede prevenir el problema y qué hacer en cada etapa. También quedó claro que la solución llegará colectivamente, porque las buenas prácticas tendrán resultados si se realizan a nivel regional, lo que supone un desafío interesante para un sector que sabe trabajar en red.
Sobre este tema, el Congreso trajo también a Paulo Garollo, uno de los principales expertos
en esta plaga de Brasil, un país que lidia desde hace casi tres décadas con este problema. Más allá de todas las recomendaciones que brindó, el especialista aportó tranquilidad, no solo en el sentido de que se puede seguir creciendo en área sembrada y producción a pesar de la chicharrita, sino que, en su país, que es el segundo mayor productor del mundo, en cada nueva región que afectó la chicharrita hizo un daño muy grande la primera vez, hasta que en las siguientes se aprendió a convivir y controlarla.
La cadena del maíz y la del sorgo son claves para el crecimiento del país, generan valor agregado, divisas y, sobre todo, desarrollo humano y profesional. Somos optimistas y confiamos en que el talento colectivo seguirá encontrando soluciones a los problemas que surgen, así como agregando valor en los diversos eslabones de ambas cadenas, que tienen tanto más por crecer.
¿El año del sorgo? Secretos de un cultivo con soluciones del lote al mercado
El sorgo redobla la apuesta en la próxima campaña. De la mano de Advanta y Tobin, te contamos las perspectivas del cultivo, tips de manejo y las últimas novedades en tecnología de semilla que prometen gran performance de rendimiento, control de malezas y protección frente a pulgón amarillo.
La siembra de sorgo se viene fortaleciendo en Argentina en los últimos años, impulsada por una serie de factores que van desde el lote al mercado. La renovada expectativa está puesta en la fuerte demanda de China, la plasticidad de destinos -tanto para consumo humano como animal- y las mejoras en las dinámicas comerciales. Un ejemplo de esto es la reciente actualización de los estándares de calidad en
los futuros sobre sorgo con entrega del Matba-Rofex, que proporciona una herramienta para la formación de precios en el marco de un mercado institucionalizado.
A campo, las virtudes del sorgo son muchas: su alta tolerancia a condiciones climáticas poco favorables, su aporte a la calidad del suelo -gracias a la gran cantidad de rastrojos
MANEJO DE CULTIVOS
REVISTA AAPRESID 50

y su estructura radicular- y su capacidad para almacenar carbono, entre otras. En cuanto a su eficiencia en el uso del agua, consume menos que el maíz, el trigo o la soja. Además, cuenta con un “mecanismo de latencia” que le permite pausar su crecimiento por completo ante una sequía excesiva y retomarlo cuando el agua se hace presente.
La inclusión de sorgo en las rotaciones demostró que también favorece las cualidades fisicoquímicas del suelo. Por un lado, su raíz en “cabellera” contribuye a regenerar la estructura y a formar grietas que incrementan la velocidad de infiltración del agua, mejorando la porosidad superficial. Además, la alta relación carbono/ nitrógeno (C/N) de los rastrojos promueve una descomposición lenta, favoreciendo la reposición de los niveles de materia orgánica en el suelo. Cuando se destina a la cosecha de grano, el sorgo aporta un gran volumen de rastrojo en superficie, lo que ayuda a mitigar la erosión hídrica y eólica, disminuyendo significativamente las pérdidas de agua del suelo por evapotranspiración.
Expectativa para el ciclo 2024/25
En esta campaña, el impacto del spiroplasma en el maíz está aumentando el interés de los productores en buscar alternativas a la rotación para frenar la problemática. Algunos productores llegan al cultivo por primera vez, mientras que otros regresan tras varias campañas. En ambos casos, deberán tener en cuenta los avances biotecnológicos que revolucionaron el manejo en los últimos años y prestar atención a algunas claves para optimizar los resultados.
Fecha de siembra y elección del híbrido
En sorgo, determinar la fecha de siembra es un punto crítico debido a su relación con la oferta de agua durante el desarrollo del cultivo. La “latencia” mencionada anteriormente, es una característica muy positiva, pero hay que saber manejarla. Si un sorgo se detiene por completo en una época de altas temperaturas, como puede ser en enero o cerca de la floración, se generan pérdidas de rendimiento. Por eso, en el Norte, mientras más temprano se siembre, mejor. En fechas de siembra temprana, a principios de octubre, la clave es potenciar el rendimiento con híbridos de ciclos más largos.
En siembras de mediados de noviembre a principios de diciembre, la elección del híbrido es aún más importante, ya que se debe optar por ciclos intermedios a cortos.
Al igual que en el maíz, cuanto más largo es el ciclo del híbrido, mayor es el potencial de rendimiento. Por eso, para determinar fechas de siembra y ciclos, es importante que producto-

REVISTA AAPRESID 52

res y asesores estén en contacto con los referentes zonales de las empresas semilleras para analizar la humedad del suelo y la ventana de siembra, y así determinar qué híbrido se adapta mejor al planteo.
Un dato importante: si se siembra bien temprano, se evita la humedad del otoño que puede ocasionar enfermedades de fin de ciclo, colonización de hongos y problemas de vuelco. De todos modos, al sembrar temprano hay que considerar la mayor probabilidad de sufrir las últimas heladas. Es fundamental conocer bien la zona y el promedio histórico de heladas para evaluar el mejor momento para encarar la siembra, siempre considerando llegar a marzo o principios de abril con un cultivo ya avanzado en madurez fisiológica.
Advanta: el futuro comienza con la semilla
Control de malezas y pulgón amarillo
El combate a las malezas es otro de los puntos clave del cultivo. Frente a esta problemática, la llegada de los sorgos con tecnología Igrowth de Advanta, otorgó facilidad al manejo. Antes, el productor se veía limitado a realizar aplicaciones a la siembra con uno o dos principios activos, lo que no garantizaba un control eficaz de malezas y normalmente resultaba en pérdida de rendimiento y menor coeficiente de logro. Hoy en día, existen sorgos con tolerancia a herbicidas, específicamente de la familia de las imidazolinonas, lo que permite trabajar en preemergencia y en postemergencia temprana.
Con este tema resuelto, llega el desafío del pulgón amarillo, la plaga número uno del cultivo y con la que el productor convive por cuarta campaña consecutiva. Este insecto posee una tasa de reproducción muy alta y veloz, y afecta notoriamente los rendimientos de cultivos que no son monitoreados con especial atención.
Para combatirlo, Advanta presentó semillas con tecnología Aphix en 2023, que minimiza el uso de insecticidas. En múltiples ensayos a nivel país, se observó que en híbridos convencionales se requieren tres aplicaciones de insecticidas contra pulgón, mientras que en híbridos Aphix solo una. Este año, Advanta presentó el primer híbrido IGAX, que incluye igrowth + Aphix, una combinación de tecnologías para un híbrido que proporciona protección contra malezas y pulgón amarillo, además de un rendimiento superior al promedio de cualquier híbrido granífero.
 Figura 1: Ensayo de evolución de dinámica poblacional de Pulgón amarillo en sorgo. Martín Galli - Campaña 2022-23
Figura 1: Ensayo de evolución de dinámica poblacional de Pulgón amarillo en sorgo. Martín Galli - Campaña 2022-23
REVISTA AAPRESID 54

Figura 2: Rendimiento alcanzado en los diferentes tratamientos evaluados en sorgo granífero.
Eficiencia de cosecha
La eficiencia de cosecha es uno de los puntos en los que queda un largo trecho por recorrer para cerrar la brecha de rendimiento con el potencial genético disponible. Algunos productores hoy están logrando 12/13 mil kg por hectárea. Es importante realizar una cosecha prolija para evitar pérdidas por cola y penalizaciones por material extraño. En esto también la genética también puede ayudar, ofreciendo mayor despeje de panoja para optimizar el trabajo de las máquinas.
No hay dudas de que la campaña 2024/25 se perfila como el año del sorgo, con el objetivo de alcanzar los 2 millones de hectáreas. Una meta alta, pero respaldada por conocimiento, tecnología y mercado.
RAGT- Tobin: un híbrido para cada necesidad
Sorgo granífero (sorgo de cosecha)
En la década del 80, el sorgo granífero llegó a abarcar 3,3 millones de hectáreas, reduciéndose a 400.000 en 2014, antes de la firma del protocolo con China. Desde entonces, con un mercado cierto y muy buen precio, la superficie ha crecido casi a un millón de hectáreas.
La tecnología igrowth® mejoróp el manejo de malezas en 2018, y desde el 2020, tras el disparo de la amenaza del pulgón amarillo, Tobin desarrolla la tecnología Sprotect®. En 2023, ya siendo parte de RAGT -la compañía multiespecie francesa-, Tobin lanzó la línea SFull, que combina Sprotect® con igrowth®, ofreciendo una solución completa para el control de malezas.
La mayor difusión del cultivo se dio en las provincias de Entre Ríos, centro norte de Santa Fe, Santiago del Estero, Chaco y NOA. Este año, con la profundización del problema de la chicharrita (presente desde hace más de 40 años), la producción de maíz de segunda quedó des-
Sorgo doble propósito (cosecha y ensilaje)
Los sorgos doble propósito sirven para cosecha de grano seco, grano húmedo en ensilaje, y planta completa, también en ensilaje. El silaje de grano húmedo se realiza con humedad del 25% al 32%, facilitando la ruptura del grano para ser atacado por bacterias y con una calidad similar
trozada. Esto impulsó una demanda totalmente inesperada de sorgo, por ser la gramínea más cercana al maíz y con valor nutritivo similar, si es manejado correctamente. Para dicha tarea, es crucial seguir algunas recomendaciones, como: respetar las épocas de siembra recomendadas por los semilleros, trabajar con las densidades estipuladas (es muy común ver sorgos demasiado tupidos que producen panoja chica, largos entrenudos, excersión de la panoja, y riesgo de vuelco), fertilizar y controlar las malezas. También es fundamental hacer los monitoreos periódicos, controlar la Spodoptera -que ataca el cogollo de la planta, pulgón y mosquita-, manejar desecantes si fuera necesario y cosechar el sorgo en el momento oportuno. Tobin ofrece tres híbridos con tecnología Sprotect® (tolerantes al pulgón amarillo del sorgo): TOB 63 T, TOB 66 T y TOB 49 T, y dos con igrowth® (resistentes a las imidazolinonas): TOB 69 T y TOB 1062 IG.
al mejor silo de maíz. El silaje de planta completa se debe realizar con un tercio de la panoja seca.
En este segmento, Tobin ofrece un híbrido de la línea Sprotect® (con tolerancia a pulgón): TOB 78 DP, y dos de la línea Sfull (con tecnologías Sprotect® + igrowth®): TOB 1078 IGSP para cosecha, y TOB 1074 IGSP específicamente doble propósito.
REVISTA AAPRESID 56
Sorgos forrajeros y sileros
En Argentina se siembran aproximadamente un millón de hectáreas de sorgos sileros y forrajeros, estos últimos destinados principalmente al pastoreo directo. Estos sorgos son muy requeridos si la salida del invierno es muy mala por sequía y heladas, siendo los primeros en ofrecer pasto entre los 40 y 60 días de sembrado. Los pulgones son una amenaza significativa, y se debe tener cuidado al fumigar ya que no hay mucha información sobre pastoreos de distintas categorías inmediatas a la fumigación. Por eso se recomiendan los sorgos Sprotect®, tolerantes al pulgón al pulgón amarillo.
Tobin desarrolla dos híbridos Sprotect® de tipo sudangrass, Tala SP y FACA SP fotosensitivo. Asimismo, la calidad fue mejorada por los BMR, con menor lignina y mayor digestibilidad, mejorando el rendimiento para producción de carne y leche. Para este objetivo, Tobin ofrece los híbridos FACA BMR y TOB 171 BMR.

Sorgos con menor lignina y mayor digestibilidad con mayor rendimiento para producción de carne y leche.

Los híbridos sileros TOB PADRILLO MAX Y TOB MATRERO MAX brindan tolerancia al pulgón, con muy buen porcentaje Brix de azúcar en sus tallos.

REVISTA AAPRESID 58
Los sorgos sileros, debido a su altura, no son aptos para cosecha ni como doble propósito. Sirven específicamente para picado de planta completa, con mucha más fibra en relación a los granos, y en algunos casos, con tallos azucarados que mejoran la palatabilidad. Es también muy importante que sean tolerantes al pulgón, pues resulta imposible fumigar materiales de altura entre 3 y 5 metros según las regiones. Tobin ofrece los híbridos sileros TOB
PADRILLO MAX Y TOB MATRERO MAX con tolerancia al pulgón y con buen porcentaje Brix de azúcar en sus tallos.

Agradecimientos:
Agradecemos a Advanta y RAGT-Tobin por sus valiosos aportes en esta nota.
A controlar maíces guachos para combatir el achaparramiento del maíz
La eliminación de los maíces voluntarios, reservorios del vector y la enfermedad, es una de las claves para su control y el momento de comenzar es ahora.
NOS ACOMPAÑAN










MANEJO DE PLAGAS
REVISTA AAPRESID 60
El achaparramiento del maíz se convirtió en la principal amenaza para los productores maiceros de Argentina. Solamente entre marzo y abril, esta enfermedad provocó una caída de 6,5 millones de toneladas en la producción nacional, según datos de la Bolsa de Comercio de Rosario, y no se sabe aún cuánto más afectará al ciclo maicero 23/24.
Esta enfermedad, transmitida por la chicharrita Dalbulus maidis, es una de las más temidas por los productores por su enorme potencial de daño: las pérdidas de rendimiento pueden superar el 70%.
Una de las claves para el manejo de esta enfermedad, o complejo de enfermedades, ya que no es la única que transmite la chicharrita, es el control de dicho vector, en particular, el control de maíces guachos o voluntarios, reservorios del vector y la enfermedad.
Maíces guachos hospedando numerosas chicharritas (Dalbulus maidis) transmisoras de la enfermedad que pone a la producción de maíz en jaque.

Con los cañones apuntados al vector
De cara a la próxima campaña, es tiempo de comenzar a planificar las estrategias de manejo, apuntando a reducir la población del vector y el inóculo de la enfermedad.
La chicharrita se reconoce por su tamaño muy pequeño, alcanzando no más que 3 a 4 mm de largo. El adulto es color crema translúcido con dos puntos más oscuros sobre la cabeza, con las alas más largas que el abdomen.
La hembra puede colocar hasta 600 huevos, presentando por lo menos siete generaciones desde septiembre a mayo. En ausencia del cultivo de maíz, sobrevive migrando a largas distancias, o bien entra en diapausa, pudiendo estar hasta 5 semanas en estado de dormancia en rastrojos de maíz y otros hospedantes, para luego colonizar el maíz siguiente.
Las ninfas nacen libres del patógeno y, al igual que el adulto, lo adquieren al alimentarse de plantas enfermas. El adulto sobrevive en promedio 45 días, aunque los invernantes pueden llegar a sobrevivir hasta 90-120 días.
En este sentido, todos los especialistas coinciden en que una de las prácticas más relevantes para romper el ciclo biológico del insecto es justamente la eliminación de los maíces voluntarios o guachos. Es decir, el control de
Regulación de la cosechadora, el primer paso para controlar maíces guachos
aquellas plantas originadas a partir de espigas rotas que caen al suelo o granos perdidos durante la cosecha y/o su transporte. Estos terminan germinando en los lotes, e incluso en banquinas y áreas urbanas.
El maíz voluntario actúa como un "puente verde" entre una cosecha y otra, albergando tanto al vector, como a los agentes causales del achaparramiento, convirtiéndose en fuente de inóculo.
El control de plantas guachas comienza en la cosecha de maíz de la temporada anterior. Durante este proceso, es crucial una adecuada regulación de la cosechadora para evitar la caída excesiva de granos en el campo y la ruptura y caída de espigas cuyos granos luego germinan de forma escalonada cuando se dan las condiciones adecuadas; por lo que también es importante controlar los lotes posteriormente.
De acuerdo al informe elaborado por los especialistas Juan Pablo Vélez (AGDI Agroeficiencia) y Santiago Tourn (Mecatech Agroconsultora) las prácticas recomendadas para la adecuada regulación de la cosechadora incluyen: la inspección previa estática del cabezal, ajustes del cabezal en el lote, ajuste de sistemas de trilla, separación y limpieza, monitoreo constante, capacitación del personal y acompañamiento técnico especializado.
REVISTA AAPRESID 62
Control químico de plantas voluntarias
Es importante el control de plantas voluntarias tan pronto como aparezcan. En casos donde la infestación de maíces guachos sea significativa, el uso de herbicidas selectivos como graminicidas es una herramienta efectiva para su control.
Idealmente, el control del maíz voluntario se debe realizar, como máximo, hasta cuando la planta tiene 3 o 4 hojas. A veces, cuando se da una germinación escalonada, se dejan avanzar más para “aprovechar la aplicación”, lo que no se recomienda ya que da la oportunidad al vector de desarrollar una nueva generación.
Asimismo, la eficacia del control químico con herbicidas graminicidas también está relacionada con el estado fenológico del maíz, siendo más eficaz cuando se aplica en los primeros estados vegetativos (hasta 3 hojas). Tanto los FOPs como DIMs muestran una eficacia similar en el control hasta el estado vegetativo. En estadios de desarrollo más avanzados, se recomienda preferentemente FOPs, que tienden a presentar una mayor eficacia.
Spiroplasma en Argentina: ¿Cómo fue el camino recorrido?
Spiroplasma es una enfermedad conocida desde mediados del siglo pasado, endémica de América y que se encuentra distribuida del sur de Estados Unidos hasta Argentina. En nuestro país fue vista por primera vez en la década del 90 en la región del NOA.
Siempre fue considerada una enfermedad secundaria, pero en la campaña 2006/2007 y
Estos grupos de herbicidas son absorbidos por las hojas, para ser traslocados luego hacia los puntos de crecimiento paralizándolos, y no tienen efecto residual en el suelo. Es importante tener en cuenta que en lotes que vienen de maíces Enlist (resistentes a haloxifop), se deben utilizar alternativas para su manejo. Siempre prestar atención a los principios básicos de la aplicación, como las condiciones climáticas adecuadas, la elección de la boquilla de aplicación correcta, la cobertura de las gotas, la presión, el volumen de caldo, uso de adyuvantes, etc.
Desde la REM destacan que el manejo adecuado de los maíces guachos no solo contribuye a la prevención del achaparramiento en el maíz, sino que también puede tener un impacto positivo en la rentabilidad y la productividad de los cultivos. Con una combinación de acciones durante la cosecha y una planificación cuidadosa para la próxima temporada, se puede reducir significativamente el riesgo.
luego en 2018/2019 y en 2019/2020 se presentó con una intensidad inusual, principalmente la región central del Chaco, donde pasó de “secundaria” a adquirir una relevancia crítica, debido a las pérdidas de rendimiento que ocasiona.
Los mapas de la Red de Manejo de Plagas de Aapresid (REM), que relevan más de 29 millones de hectáreas en todo el país, muestran que para la campaña 21/22 la presencia de la chicharrita Dalbulus maidis, estaba delimitada a las regiones del NEA y NOA (Chaco, Santiago
del Estero, Tucumán, Salta), sumando algunos departamentos del norte santafesino.
En 2022/23, la tradicional encuesta a socios de Aapresid liderada por la REM, comenzaba a encender las alarmas: Dalbulus maidis apareció como el insecto de mayor importancia en maíz tardío detectado por los productores Aapresid del NEA (36%), ubicándose por encima de plagas consideradas relevantes como Spodoptera, Helicoverpa o Dichelops.
Por otro lado, Santana et al. (2018) llevaron a cabo un análisis de la nueva distribución del vector, basado en modelos climáticos que proyectaban un aumento de temperatura debido al calentamiento global. Como resultado, el estuEscuchá el podcast Integrando Manejos de Aapresid, donde el Ing. Agr. Dario Oleszczuk y el Ing. Agr. Esteban Jauregui, Chacra Bandera
dio ya anticipaba un desplazamiento en la zona de adaptación de este insecto para el año 2050.
“En América del Sur, el cambio climático disminuirá las áreas adecuadas para la plaga, especialmente en Brasil. Sin embargo, Argentina, Chile, Colombia, Ecuador, Perú y Venezuela tendrán pequeñas áreas altamente adecuadas para la chicharrita del maíz”, describe la publicación.
Este análisis no sólo destaca el impacto directo del cambio climático en la distribución y gravedad de las plagas que afectan la agricultura, sino que se adelantó unas décadas, llegando antes de lo que se presumía.
¿Querés más información sobre la chicharrita del maíz?
Aapresid, conversan sobre el control y manejo de la chicharrita del maíz.

REVISTA AAPRESID 64

Una plaga disruptiva que nos desafía a volver a aprender
Desde Tucumán, lugar donde la chicharrita del maíz fue reportada por primera vez en Argentina, la Estación Experimental Agroindustrial Obispo Colombres, busca soluciones para controlarla.

Autores: Casmuz, Augusto S.¹; Martín A. Vera¹; Ignacio Romero¹; Nicolás Campero¹; Cristián M. Medrano¹; Emmanuel Cejas Marchi¹; Pablo Álvarez Paz¹; Pedro J. Ale
Reuter¹; José M. López Lomenzo¹; Gerardo A. Gastaminza¹; Franco S. Scalora¹; Daniel E. Gamboa¹ y Mario R. Devani¹.
¹Estación Experimental Agroindustrial Obispo Colombres, EEAOC, Las Talitas (Tucumán - Argentina). E-mail: acasmuz@eeaoc.org.ar
MANEJO DE PLAGAS
REVISTA AAPRESID 66

La chicharrita del maíz, Dalbulus maidis (De Long & Wolcott), es el principal vector del Corn Stunt Spiroplasma (CSS), una enfermedad persistente y en aumento en los cultivos de maíz, especialmente al norte del paralelo 30°, causando hasta un 100% de daño (Nault & Bradfute, 1979; Lenardon et al., 1993; Gimenez Pecci et al., 1997). Además del CSS, D. maidis puede transmitir otros patógenos como el fitoplasma (Maize Bushy Stunt Mycoplasm) y el virus del rayado fino (MRFV), que pueden presentarse solos o de manera conjunta, provocando el achaparramiento del maíz (Hruska et al., 1996). Recientemente, también se detectó en Argentina el virus del mosaico estriado del maíz (MSMV), transmitido por D. maidis (Ruiz Posse et al., 2023).
D. maidis fue reportado por primera vez en Argentina en Tucumán, en cultivos de remolacha azucarera (Omán, 1948). Posteriormente, se registró su presencia en Jujuy, Salta, Tucumán, Chaco, Catamarca, Santiago del Estero, Santa Fe y Buenos Aires, en cultivos de maíz, teosinte y malezas aledañas (Virla et al., 1990/1991; Gimémez Pecci et al.,1997).
D. maidis es un insecto monófago que se alimenta y multiplica únicamente en especies del género Zea, incluyendo el maíz y sus ancestros silvestres (teosintes). En Tucumán, tiene al menos cinco generaciones entre noviembre y mayo; los adultos de la última generación sobreviven el invierno refugiados en malezas,




cultivos invernales y vegetación nativa, desde donde colonizan a los cultivos de maíz en la primavera siguiente (Virla et al., 2003).
Ebbert y Nault (1994) demostraron que algunas poblaciones de D. maidis pueden resistir unas pocas horas a temperaturas de -5 °C con baja humedad ambiente y sobrevivir sin alimentarse durante varios meses a temperaturas entre 10 y 20 °C. Además, los individuos infectados con CSS aumentan considerablemente su supervivencia, en especial las hembras.
El aumento de los niveles poblacionales de D. maidis y la incidencia de las enfermedades que transmite en el maíz requieren la implementación de medidas integrales y regionales para minimizar sus daños. Estas medidas se detallan en la Figura 1 y se desarrollarán a continuación.

REVISTA AAPRESID 68
Figura 1. Esquema que hace referencia a las diferentes medidas que se debe adoptar para el manejo integrado de Dalbulus maidis y el complejo de patógenos causales del achaparramiento del maíz.

Reducción del inóculo y vector: manejo de las poblaciones de D. maidis
Como se mencionó anteriormente, D. maidis es un insecto monófago que solo se alimenta y multiplica en plantas de maíz. La ausencia de su hospedero por períodos prolongados (90 a 100 días) puede impactar significativamente en la evolución de este vector. En función de ello, se sugiere la adopción de las siguientes estrategias:
Control de pérdidas de cosecha en lotes de maíz
Los daños causados por el achaparramiento del maíz en la campaña actual hacen suponer que durante la cosecha del cultivo quedarán mayores cantidades de espigas y granos en los lotes, favoreciendo la proliferación de los maíces “guachos”. Es fundamental minimizar las pérdidas de cosecha en lotes de maíz, para reducir las poblaciones de maíces “guachos” y limitar la multiplicación del vector.
Control de maíces “guachos”
El monitoreo frecuente de los lotes donde se cosechó maíz permitirá detectar tempranamente plantas de maíz “guacho” donde se desarrollará D. maidis y el patosistema del achaparramiento del maíz (Figura 2). En zonas con bajas probabilidades de heladas durante el invierno, no se debería dejar a los maíces “guachos” a merced de ser controlados por este fenómeno, ya que si las heladas no ocurriesen en la magnitud suficiente, las poblaciones del vector seguirán incrementándose.

En los maíces “guachos” que proliferan durante la primavera, la detección de D. maidis sobre estas plantas podría sugerir la incorporación de algún insecticida de contacto al momento de controlar los “guachos”. En este sentido, se considera relevante la incorporación de aplicaciones dirigidas, tecnología desarrollada para el control de malezas en barbecho, que minimizaría el impacto de esta práctica sobre el ambiente.



Figura 2. (A) Maíces “guachos” con adultos de Dalbulus maidis; y (B y C) maíces “guachos” con síntomas característicos del achaparramiento del maíz.

Manejo de especies vegetales que actúan como refugio para D. maidis
El control de malezas invernales y primaverales, minimizaría la ocurrencia de los adultos de D. maidis en los lotes en cuestión (Figura 3). En situaciones con cultivos invernales, se sugiere el monitoreo de D. maidis, información que permitiría planificar la inclusión de algún insecticida de contacto y con baja persistencia para actuar sobre los adultos D. maidis que sobrevivieron durante el invierno en estos cultivos.
REVISTA AAPRESID 70




Vacío sanitario
Esta práctica es esencial en áreas con alta incidencia de D. maidis y del patosistema del achaparramiento del maíz. La ausencia de maíz durante al menos tres meses, junto con la erradicación de los maíces “guachos” y la no siembra de maíz en primavera, puede reducir significativamente el desarrollo de D. maidis y las enfermedades que transmite.
Estudios realizados por la EEAOC con trampas amarillas pegajosas en zonas con siembras de maíz en primavera, determinaron que los niveles poblacionales de D. maidis fueran hasta 10 veces mayores en comparación con áreas donde el maíz se siembra sólo en verano, resultando en pérdidas casi totales en el maíz estival (Figura 4).
Figura 3. Malezas con adultos de Dalbulus maidis refugiados.




Figura 4. Dinámica de los adultos de Dalbulus maidis capturados con trampas amarillas pegajosas desde septiembre de 2023 hasta abril de 2024 en zona con maíz estival (A y C) y en zona con maíz primaveral y estival (B y D). En las Figuras A y B se indican las fechas de siembra del maíz estival en cada zona.

Monitoreo de la fluctuación poblacional de Dalbulus maidis y su infectividad
En el proyecto conjunto de la EEAOC y los grupos CREA de la región del NOA, se estudi la dinámica de los adultos de D. maidis, a partir de la captura con trampas amarillas pegajosas en dos zonas agroecológicas del NOA (Figuras 4 y 5). Además, se analizó el porcentaje de individuos infectados con Corn Stunt Spiroplasma (CSS), a partir de técnicas de PCR (Tabla 1).
El conocimiento de la fluctuación de D. maidis y del complejo de patógenos causantes del achaparramiento del maíz a nivel regional es clave para planificar y adoptar medidas que minimicen el impacto de esta problemática en el cultivo de maíz.
REVISTA AAPRESID 72



5. Monitoreo de la fluctuación de los adultos de Dalbulus maidis durante la primavera (A) y el verano (B). Adultos capturados con trampas amarillas pegajosas (C).
Análisis por PCR. Centro de Bioinvestigaciones (UNNOBA-CICBA). Dra. Inés Catalano.

San Agustín (Maíz estival) Tucumán
Los Altos (Maíz primaveral y maíz estival) Catamarca
Tabla 1. Porcentaje de adultos de Dalbulus maidis infectivos (CSS) para las localidades de San Agustín (maíz estival) y Los Altos (maíz primaveral y maíz estival). Se indica el mes, el hospedero y la cantidad de adultos de colectados.
Figura
Localidad Provincia Mes de colecta Hospedero N° de adultos de D. maidis % de infectividad
Sep Maíz "guacho" 30 3,3% Dic Maíz "guacho" 30 10% Ene Maíz estival 30 10% Feb Maíz estival 30 30%
Sep Maíz prod. semillas 30 3,3% Dic Maíz prod. semillas 30 10% Ene Maíz estival 30 20% Feb Maíz estival 30 45%

Prácticas culturales para el manejo de D. maidis
Debido a las características biológicas de D. maidis y epidemiológicas del patosistema del achaparramiento del maíz, se debería planificar y adoptar una serie de medidas para el manejo de esta problemática en el cultivo de maíz.
Rotación de cultivos
El maíz cumple un rol clave en la sustentabilidad de nuestros sistemas productivos. Sin embargo, en zonas o en fechas de siembra con alta incidencia de D. maidis y del patosistema del achaparramiento del maíz, se sugiere la rotación con otros cultivos no hospederos de la plaga, como el sorgo, para mantener la proporción con gramíneas estivales en los sistemas productivos.
Uso de materiales de mayor tolerancia al patosistema del achaparramiento del maíz
Esta práctica cultural es uno de los pilares para el manejo del complejo de enfermedades transmitidas por D. maidis en países como Brasil y Paraguay. Aunque hay pocos materiales disponibles con algún grado de tolerancia, estos materiales han demostrado ser muy afectados en escenarios de alta incidencia de D. maidis y del patosistema del achaparramiento del maíz (Figura 6).
Las empresas de semillas están evaluando híbridos comerciales, pre-comerciales y nuevos materiales para ampliar la disponibilidad de híbridos con mejor tolerancia al achaparramiento del maíz.
REVISTA AAPRESID 74




El escalonamiento de las fechas de siembra favorece el desarrollo de D. maidis y las enfermedades transmitidas por este vector, ocurriendo incidencias mayores en las siembras más tardías (Figura 7). Por lo tanto, es recomendable concentrar la fecha de siembra del maíz para minimizar el impacto de estas enfermedades. La efectividad de esta medida depende de su adopción a nivel zonal, considerando la logística de siembra y eligiendo fechas adecuadas para asegurar que las etapas críticas del cultivo no coincidan con períodos de estrés ambiental que puedan afectar la productividad del maíz.



 Figura 6. Aspecto de las plantas y espigas de híbridos sensibles y tolerantes al achaparramiento del maíz transmitido por Dalbulus maidis.
Fecha de siembra del cultivo de maíz
Figura 7. Ensayo de maíz para evaluar el impacto de Dalbulus maidis en diferentes fechas de siembra del cultivo de maíz, campaña 2023/24. 1° FS: 26 de diciembre de 2023, 2°FS: 12 de enero de 2024 y 3°FS: 7 de febrero de 2024.
Figura 6. Aspecto de las plantas y espigas de híbridos sensibles y tolerantes al achaparramiento del maíz transmitido por Dalbulus maidis.
Fecha de siembra del cultivo de maíz
Figura 7. Ensayo de maíz para evaluar el impacto de Dalbulus maidis en diferentes fechas de siembra del cultivo de maíz, campaña 2023/24. 1° FS: 26 de diciembre de 2023, 2°FS: 12 de enero de 2024 y 3°FS: 7 de febrero de 2024.

Monitoreo de D. maidis en el maíz
Esta tarea debería comenzar desde la emergencia del cultivo, con una frecuencia al menos semanal y durante todas las fases vegetativas del maíz. Se recomienda revisar al menos 10 plantas consecutivas en 10 puntos de muestreo por lote, distribuidos en distintos sectores, incluyendo las cabeceras donde suele ingresar la plaga. El monitoreo debe ser dirigido a la observación del cogollo de las plantas del maíz (Figura 8) y, desde V4 en adelante, las hojas del estrato inferior para registrar ninfas (Figura 8). La eficacia del monitoreo mejora al realizarse en horarios con menores temperaturas, ya que la actividad de la plaga es menor en estos momentos.




REVISTA AAPRESID 76
Figura 8. Monitoreo de Dalbulus maidis en el cultivo de maíz. A) Monitoreo de adultos a partir de la revisión de los cogollos de las plantas de maíz y B) Monitoreo de ninfas a partir de la revisión del envés de las hojas del estrato inferior de las plantas de maíz.
Control de D. maidis
El impacto de D. maidis es mayor cuando las infecciones ocurren en las etapas tempranas del cultivo, por lo que es clave implementar medidas de control en dichas fases. En Brasil,
Tratamiento de semillas con insecticidas
En Argentina, las semillas de maíz suelen tratarse en origen con neonicotinoides (clothianidin, tiametoxam, imidacloprid) en dosis menores a las utilizadas en Brasil (Tabla 2). La EEAOC evaluó la efectividad de incrementar las dosis de estos insecticidas, observando una mejor performance de control con las dosis brasileñas (Figura 9)
Otro aspecto evaluado por la EEAOC fue el efecto del incremento de la dosis del TS sobre la calidad fisiológica de la semilla. Se observó que, al aumentar la dosis del insecticida en la semilla ya tratada, se puede afectar de manera
se combinan insecticidas en el tratamiento de semillas con aplicaciones foliares, lo que permite un control aceptable de D. maidis durante las fases del desarrollo del maíz.

Principio activo
significativa la calidad fisiológica de este órgano, agravándose este efecto cuando el tiempo entre el tratamiento y la fecha de siembra del cultivo es prolongado.
El SENASA, las empresas semilleras y de productos fitosanitarios, en conjunto con instituciones oficiales analizan la posibilidad de registrar dosis mayores de algunos neonicotinoides, que serán incorporados en el tratamiento profesional de las semillas para asegurar un mejor control inicial de D. maidis, sin que se vea afectada la calidad fisiológica de las semillas de maíz.
*Clothianidin 60% FS disponible solo para semilleros
Dosis registro Argentina (Insectos varios)
Dosis registro Brasil (Dalbulus maidis)
Tiametoxam 35% FS
a 1,2 cm3 pc/1000 semillas
cm3 pc/1000 semillas
Imidacloprid 60% FS 500 a 750 cm3 pc/100 kg semillas 800 cm3 pc/100 kg semillas 1,6 cm3 pc/1000 semillas 2,7 cm3 pc/1000 semillas
*Clothianidin 60% FS 0,3 a 0,8 cm3 pc/1000 semillas 1,3 cm3 pc/1000 semillas
Tabla 2. Insecticidas y dosis registradas en Argentina para el tratamiento de semillas en maíz y dosis de registro de los insecticidas en Brasil para el control de D. maidis en maíz.
800
0,7
1,3
350 a 600 cm3 pc/100 kg semillas
cm3 pc/100 kg semillas



Figura 9. Ensayo de tratamientos de semillas (TS) para el control de D. maidis. Se expresa el porcentaje de eficacia de control (Abbott) según tratamiento a los 13 días después de siembra (DDS) en V1 y a los 27 DDS en V2. Los insecticidas evaluados fueron tiametoxam 35 % FS e imidacloprid 70% WG en dosis de registro para Argentina (Arg) y en dosis registradas en Brasil (Br).
REVISTA AAPRESID 78
Tratamiento foliar con insecticidas
Una vez pasado el efecto del TS, se debe recurrir a aplicaciones foliares de insecticidas para proteger al maíz durante las etapas fenológicas más sensibles al achaparramiento, que pueden extenderse hasta V12, dependiendo de la susceptibilidad del maíz.
No existían productos registrados para el control de D. maidis en Argentina hasta hace poco. En Brasil, las dosis para D. maidis son más elevadas que las establecidas en Argentina para el manejo de otras plagas. Por este motivo, la EEAOC evaluó diferentes productos, mezclas y dosis, incluyendo carbamatos, organofosforados, fenilpirazoles, piretroides, neonicotinoides e isoxazolinas, con niveles de control generalmente bajos. Las eficacias cercanas al 60% se observan sólo bajo presiones moderadas de la plaga, disminuyendo significativamente en situaciones de alta presión de D. maidis (5 a 7 adultos por planta).
Otro aspecto a destacar es el corto período de protección que brindaron las alternativas químicas evaluadas, no superando los 7 días. Esto obligaría a realizar aplicaciones frecuentes para lograr una protección aceptable.
REFERENCIAS



Consulte las referencias ingresando a www.aapresid.org.ar/blog/revista-aapresid-n-230

Achaparramiento del maíz en contexto: entender para enfrentar mejor este desafío a los sistemas de producción

Entender las causas que contribuyeron al avance de la enfermedad en la campaña 2023/24, así como la ecofisiología del cultivo, nos ayuda a aprender de lo que pasó y a tomar mejores decisiones para la próxima campaña.
Por: Ing. Agr. M.Sc. Dra. María de la Paz Giménez Pecci¹ y Ing.
Agr. M.Sc. Jorge Mercau²
¹INTA CIAP-IPAVE, Grupo de Enfermedades en Maíz. 2INTA San Luis, Programa de Ecofisiología y Agroecosistemas.
MANEJO DE PLAGAS
REVISTA AAPRESID 80
En la campaña 2023/2024 el cultivo de maíz en Argentina experimentó un golpe duro asociado al “Achaparramiento”, que se combinó con condiciones ambientales adversas que afectaron al cultivo en una región muy amplia. El crecimiento en área de maíz con planteos tempranos y tardíos en muchas zonas, junto con la alta frecuencia de maíz guacho o voluntario (favorecido por portar el gen RR y la sequía de la campaña 2022/2023), las temperaturas moderadas de los últimos dos inviernos y el aumento de temperatura en las últimas primaveras, parecen haberse combinado para generar una explosión en la población de Dalbulus maidis, conocida como chicharrita del maíz. Esta plaga es portadora y vectora de cuatro patógenos que generan la enfermedad del achaparramiento del maíz. Además, la escasa y variable disponibilidad de agua al inicio de primavera y la falta de lluvias en las ventanas óptimas para implantar el cultivo, dieron lugar a siembras escalonadas en el tiempo en mu-

chas zonas, lo que favoreció el crecimiento de las poblaciones del vector. Sin embargo, esa escasez de agua también afectó directamente al cultivo, un factor a considerar al evaluar los daños por la enfermedad.
A lo largo del ciclo de maíz, el despliegue del área foliar y las raíces permite al cultivo la captura de recursos para crecer, la fijación del número de granos y finalmente el llenado de los mismos (Figura 1). Hasta la aparición de la panoja (VT) y los estigmas (R1), se sucede la expansión de las hojas y, desde unas cinco hojas, la elongación de los entrenudos, que las colocan a una altura creciente. Si se inicia con poca agua disponible en el suelo y ocurren muy pocas lluvias en las etapas tempranas del ciclo, los entrenudos quedan más cortos y las plantas más petisas, “achaparradas” (Figura 2a). Muy altas temperaturas en pre panojamiento, o antes del cuaje de los granos (R2-R3), incluso sin estrés hídrico, pero especialmente si coinciden
Este trabajo vuelca aspectos del webinario “Achaparramiento del maíz: integrando conocimientos” que se ensambló desde el Programa de Protección Vegetal del INTA el 16 de abril de 2024 (disponible en www.youtube.com/watch?v=E1li60noOv4&t=4818s&ab_channel=INTAArgentina)
ambos estreses, pueden causar granos salteados y/o una reducción del crecimiento que genere espigas muy chicas para el tamaño de las plantas. En este escenario, se produce un exceso carbohidratos para el llenado, ralentizando la detención de la fotosíntesis y la síntesis de antocianinas que producen tonos rojos en las hojas (Figura 2b).
Durante esta etapa crítica para el rendimiento, el estrés frecuentemente genera plantas con menos granos, bajas reservas y granos potencialmente más chicos, aumentando las pérdidas de rendimiento. Si las plantas crecie-
ron bien y cuajaron muchos granos, el estrés hídrico durante el llenado (entre R3 y R5 inclusive), especialmente combinado con muy altas temperaturas o medias elevadas, puede causar una alta removilización de carbohidratos, aceleración del llenado, corte prematuro y granos livianos. Además, al debilitarse la caña, pueden ingresar hongos en el pie (Fusarium sp., Diplodia sp., Macrophomina sp.), causando quiebre y/o vuelco (Figura 2c).

Figura 1. Esquema del ciclo del cultivo de maíz que ilustra el despliegue del área foliar (en punteado, un índice de área foliar por encima del cual se intercepta toda la luz), el crecimiento en altura y profundidad radical, la fijación de los granos y su llenado, y el impacto que pueden tener los estreses en dichas etapas.
REVISTA AAPRESID 82

Figura 2. a. Planta con entrenudos cortos por sequía, “achaparrada”. b. Plantas con espigas con granos salteados por muy alta temperatura y exceso de fuente que genera tonos rojos. c. Cultivos con estrés hídrico y térmico durante el llenado, con alta removilización, detención prematura del llenado y hasta quebrado.
Durante la campaña 2023/2024 ocurrieron estreses abióticos severos en distintas etapas del maíz, incluso dentro de una misma zona, debido al escalonamiento de fechas y la diversidad de ambientes donde se sembró. El inicio de la campaña tuvo almacenes de agua muy bajos, consecuencia de la fuerte sequía de la campaña previa, y quienes sembraron temprano, en muchos casos, lo hicieron con una recarga parcial (Figura 3a, izquierda). Además, las
Durante la campaña 2023/2024 ocurrieron estreses abióticos severos en distintas etapas del maíz, incluso dentro de una misma zona, debido al escalonamiento de fechas y la diversidad de ambientes donde se sembró.
lluvias se demoraron en algunas zonas, haciendo que, incluso para las primeras fechas de los maíces tardíos, el agua inicial fuese baja (Figura 3a, derecha), especialmente si se realizaron cultivos de servicios o cosecha previos.
Esta situación provocó que en cada región hubiese un amplio abanico de fechas de siembra. En algunos casos, quienes sembraron temprano recibieron buenas lluvias a finales de diciembre y comienzos de enero, lo que permitió un buen desempeño de los cultivos. Las siembras tardías de finales de noviembre, utilizadas al oeste del área central debido a la corta estación de crecimiento, experimentaron sequía y muy alta temperatura (Figura 3 b), especialmente alrededor de la floración. En el norte, quienes sembraron durante la primera mitad de enero también enfrentaron temperaturas muy altas, con sequía en amplias zonas y temperaturas medias altas (Figura 3 c), especialmente durante el llenado de granos. Además, a mediados de marzo, fuertes vientos volcaron algunos cultivos. De esta descripción de las condiciones ambientales y sus efectos sobre el cultivo, se desprende que en un área importante del país hubo plantas achaparradas, granos salteados, tonos rojos en el canopeo, cultivos entregados y quiebre, solo debido a estos factores abióticos.
Hubo plantas achaparradas, granos salteados, tonos rojos en el canopeo, cultivos entregados y quiebre, solo debido a estos factores abióticos.
REVISTA AAPRESID 84

Figura 3. a. Agua disponible (% en hasta 2m) al 10 de octubre (izquierda) y fin de noviembre (derecha), destacando áreas con baja agua al inicio de cultivos sembrados en esas fechas. b y c. Agua disponible media (% en hasta 2m) (izquierda), días con más de 35 ºC de máxima (puntos), y temperatura media (color mapa) en una ventana alrededor de la floración de cultivos sembrados a finales de noviembre y a comienzos de diciembre en la zona central (b) y primera mitad de enero en el norte (c), destacando áreas con estrés hídrico y térmico en floración y/o llenado de granos. Mapas diseñados por Lucas Gusmerotti, Natalia Gattinoni, y Jorge Mercau del SEPA (con sede en INTA Clima y Agua, Castelar).
La enfermedad del achaparramiento del maíz es causada por distintos patógenos, solos o en combinación, que en la mayoría de los casos generan síntomas similares a los de estrés abiótico, aunque con diferencias que permiten distinguirlos en algunos casos. El virus del rayado fino (MRFV) progresa rápidamente en la planta, por lo que, si la infección es temprana, puede provocar plantas achaparradas. Bajo el ataque de este virus, es frecuente observar espigas chicas y granos salteados. Ambos síntomas se confunden claramente con los estreses descriptos, sin embargo, las hojas presentan finas rayas a lo largo de las nervaduras, visibles al trasluz, un síntoma exclusivo de este patógeno.
Por su parte, las bacterias espiroplasma (Spiroplasma kunkelii) y fitoplasma (MBSP) proliferan en los vasos del floema, obstruyendo progresivamente el transporte de azúcares entre órganos. El xilema, en cambio, mantiene su funcionalidad. Este progreso más lento hace que solo en ataques muy severos y tempranos, o en materiales muy susceptibles, se observe achaparramiento causado por este patógeno. Los

primeros síntomas son el enrojecimiento de las hojas, que al igual que cuando hay pocos destinos, comienzan a sintetizar antocianinas al no poder exportar los productos de la fotosíntesis. En condiciones de elevada temperatura, infección temprana, híbridos muy susceptibles o altas poblaciones de chicharrita, puede observarse un síntoma exclusivo de la infección por espiroplasma: estrías cloróticas que nacen en la base de la lámina, de borde irregular, que se extienden hasta la punta foliar.
En infecciones de ambas bacterias, la espiga no recibe fotoasimilados, lo que corta prematuramente el llenado, impactando fuertemente en el rendimiento. Esto se acentúa cuando las espigas afectadas no se logran cosechar. La planta se entrega de forma anticipada, hasta tres semanas antes que las no infectadas. Un aspecto relevante para diferenciar de estreses ambientales es que la planta no logra movilizar las reservas del tallo, por lo que la caña en principio no se debilita, aunque con el tiempo el ambiente podría favorecer a algún patógeno secundario.
REVISTA AAPRESID 86

Comentarios finales
El golpe que sufrió el cultivo de maíz en la última campaña representa un desafío para las próximas campañas. Sin embargo, la proyección futura depende en parte de cómo interpretemos lo que nos pasó, algo para lo que esperamos que este artículo sea de utilidad. También serán cruciales las acciones que emprendamos para manejar la dispersión del vector, un aspecto central del manejo, y para incorporar mejoras en la genética de nuestro germoplasma de maíz. Sobre este último punto, es importante destacar que la tecnología ya existe, y se han realizado al menos dos pruebas completas del concepto (Barontini et al., 2021, Oleszczuk et al., 2020, https://doi.org/10.1371/journal.pone.0234454). La integración de conocimientos que se está dando en el país desde distintas disciplinas y organismos, junto a aquellos que toman decisiones en todas las escalas, será clave para enfrentar este complejo desafío con el mayor éxito posible.

Beauveria bassiana, una alternativa eficaz contra la chicharrita dentro de un manejo integrado
Inspirados en la famosa frase de Albert Einstein: “No esperes resultados distintos si aplicas las mismas prácticas”, Beauveria bassiana, un hongo entomopatógeno, aparece como una alternativa eficaz e innovadora para el control de la chicharrita del maíz.
Por Ing. Agr. Juan Pablo Brich-
ta MN 16724
CEO Agro Advance Technology
Como productores, asesores y miembros de la cadena de maíz, enfrentamos la creciente amenaza de la chicharrita (Dalbulus maidis).
Esta plaga, aunque no es nueva, ha mostrado un desarrollo alarmante con una expansión exponencial y la probabilidad de seguir causando serios daños.
Quienes estamos involucrados en la aventura agraria, sabemos reconocer cuando fuimos exitosos con determinadas estrategias y recursos disponibles, así como cuando -por el contrariono conseguimos resolver el problema.
MANEJO DE PLAGAS
REVISTA AAPRESID 88

Como dice la famosa frase atribuida a Albert Einstein: “No esperes resultados distintos si aplicas las mismas prácticas”. La insistencia en el uso de productos que no han demostrado soluciones definitivas ni atenúan significativamente los efectos de la plaga podría estar alineada con esta reflexión.
En este contexto, la incorporación de nuevas alternativas de control, como la aplicación de Beauveria bassiana, un hongo entomopatógeno, toma relevancia para el control de la chicharrita del maíz. La eficacia de este ento-
mopatógeno puede variar dependiendo de factores como las condiciones ambientales, la concentración y formulación del producto, la metodología de aplicación así como la etapa de desarrollo de la plaga. Sin embargo, la información relevada y la experiencia adquirida indican que Beauveria bassiana puede ser una herramienta altamente efectiva.
Eficacia y estrategias de aplicación de Beauveria bassiana
La eficacia de Beauveria bassiana puede manifestarse entre 3 a 5 días, dependiendo de la concentración de las esporas o conidios aplicados, las condiciones climáticas y la susceptibilidad de la plaga. Aunque el control biológico con Beauveria bassiana puede no ser inmediato, ofrece beneficios comprobables a muy corto plazo y muchos más a largo plazo en términos de sustentabilidad y preservación del medioambiente.
Para una estrategia agronómica efectiva, es importante aplicar Beauveria bassiana desde
la etapa vegetativa del maíz, particularmente desde la emergencia hasta la V8 (desarrollo de 8 hojas completamente expandidas). Estas etapas son críticas para el establecimiento del cultivo y pueden ser vulnerables a los ataques de la chicharrita. Por lo tanto, la aplicación en este período puede prevenir infestaciones tempranas y limitar el daño.
Adoptar un enfoque integrado que combine productos de síntesis química y biológicos es clave. Los productos químicos ofrecen un control rápido y efectivo en situaciones de alta in-

REVISTA AAPRESID 90
festación; sin embargo, un uso excesivo puede tener efectos negativos en el medioambiente.
Por lo tanto, integrar productos biológicos a base de Beauveria bassiana en el manejo de la chicharrita del maíz puede reducir la dependencia
Volúmen de caldo y uso de coadyuvantes
El volumen de caldo utilizado en la aplicación de productos fitosanitarios, ya sea de síntesis o biológicos, es crucial para la eficacia del tratamiento. Trabajos científicos en Brasil han demostrado la ventaja de utilizar volúmenes mayores a los habitualmente utilizados en Argentina. Con más de 100 litros/ha, según diversos autores, se mejora la dispersión y la penetración del principio activo en el follaje de los cultivos. Además, un mayor volumen de caldo puede ayudar a reducir la deriva, minimizar el impacto ambiental y la exposición no deseada a otros organismos.
El tipo de coadyuvante también es importante. Los surfactantes, por ejemplo, mejoran la adherencia y absorción del producto en las hojas, aumentando su efectividad. Algunos coadyuvantes también actúan como agentes humectantes o dispersantes, lo que facilita una mejor distribución del producto en la superficie de las plantas.
de los insecticidas químicos y minimizar impactos negativos. Además, la rotación de diferentes modos de acción y el uso selectivo de ambos tipos de productos pueden prevenir la aparición de resistencia en la población de chicharritas y garantizar un control efectivo a largo plazo.
La capacidad de limpieza del insecto es otro punto a tener en cuenta. Las chicharritas, al igual que otras plagas, tienen mecanismos de defensa y comportamientos de limpieza que pueden reducir la exposición al producto aplicado, por lo que una adecuada selección de coadyuvantes y volúmenes de caldo es fundamental para optimizar un control efectivo de la plaga y maximizar los resultados del tratamiento.
Para garantizar una aplicación uniforme y una cobertura completa de las plantas, se recomienda utilizar equipos de aplicación adecuados y ajustar la cantidad de caldo según las necesidades específicas de cada situación y las recomendaciones del asesor técnico, así como las indicaciones del marbete del producto fitosanitario utilizado.

Medidas de prevención y monitoreo
Antes de la siembra de maíz, se debe implementar una estrategia de manejo preventivo y monitoreo para controlar la población de chicharritas. Aquí hay algunas recomendaciones clave:
Monitoreo de poblaciones: Realizar un monitoreo regular de los lotes afectados para evaluar la densidad poblacional de chicharritas y detectar cualquier aumento significativo. Esto puede hacerse mediante la observación directa de las plantas y la utilización de trampas cromáticas (amarillas).
Identificación temprana: Capacitar al personal para reconocer los síntomas de daño, como el enrollamiento de las hojas o la presencia de exudados pegajosos, permitiendo una acción rápida y efectiva.
Manejo de malezas y residuos de cultivos: Limpiar adecuadamente los lotes afectados,
eliminando malezas hospederas y restos de cultivos anteriores que puedan servir como refugio o fuente de alimento para las chicharritas.
Rotación de cultivos: Utilizar la rotación de cultivos para interrumpir el ciclo de vida de las chicharritas, reducir su presión sobre los cultivos y mejorar la salud del suelo.
Uso de cultivos de servicio: Implementar cultivos de servicio para proporcionar refugio y alimento alternativo para los enemigos naturales de las chicharritas, como depredadores y parasitoides.
Aplicación de tratamientos preventivos: Considerar la aplicación de tratamientos insecticidas o bioinsecticidas preventivos en los lotes afectados si se detecta una alta densidad de chicharritas durante el monitoreo.
REVISTA AAPRESID 92
Copar la parada
Algunos relevamientos que venimos observando sugieren que la incorporación de microorganismos endófitos, como Gluconacetobacter, al manejo integrado de la chicharrita del maíz puede ofrecer resultados significativos. Estos beneficios se reflejan especialmente en la mejora de la calidad de la metagenómica interna de la planta. A continuación, se presentan algunas implicancias clave de esta estrategia:
1
Competencia microbiana: Los microorganismos endófitos pueden competir con los patógenos transmitidos por la chicharrita, como bacterias y virus que colapsan los vasos conductores (floema). Al colonizar el interior de los haces vasculares, los endófitos ocupan nichos ecológicos y compiten por recursos, reduciendo la capacidad de los patógenos para establecerse y desarrollar enfermedades.
3
Estimulación del sistema inmunológico de la planta: Algunos microorganismos endófitos pueden activar respuestas inmunológicas en la planta, fortaleciendo su sistema inmunológico y aumentando su capacidad para defenderse contra patógenos. Esto mejora la resistencia del maíz a enfermedades transmitidas por vectores y reduce su susceptibilidad a infecciones.
2
Producción de metabolitos secundarios: Muchos microorganismos endófitos producen metabolitos secundarios con propiedades antimicrobianas y antivirales. Estos metabolitos pueden tener efectos beneficiosos en la salud y la resistencia de la planta, inhibiendo la proliferación de patógenos y reduciendo la transmisión de enfermedades.
4
Modulación del microbioma de la planta: La incorporación de endófitos influye en la composición y la diversidad del microbioma del maíz, es decir, la comunidad de microorganismos que habitan en su interior. Una metagenómica interna más diversa y equilibrada contribuye a la salud y bienestar de la planta, reduciendo su vulnerabilidad a enfermedades y mejorando su capacidad de adaptación a condiciones ambientales cambiantes.
En resumen, esta estrategia complementaria fortalece la salud de los cultivos de maíz y mejora la resistencia de las plantas a enfermedades transmitidas por vectores.
Nuestros ensayos y datos confiables a partir de resultados concretos respaldan nuestra propuesta de “defensa y ataque” contra la chicharrita, donde la Beauveria bassiana se posiciona como un agente clave en el control de la plaga. Esta estrategia comprende un manejo integrado que no sólo controla al vector, independientemente de su origen (síntesis o biológico), de contacto o sistémico, sino que también valora la inclusión de microorganismos benéficos al sistema.
La aplicación de microorganismos endófitos, tanto en la semilla como posteriormente en estados vegetativos tempranos, puede contribuir a ocupar los haces vasculares y competir con alguno de los patógenos infectantes.
El actual contexto nos interpela y nos desafía a innovar, como bien lo expresó Albert Einstein: quizás debamos hacer algo distinto y no permanecer sujetos a viejas recetas.
REVISTA AAPRESID 94

En resumen, esta estrategia complementaria fortalece la salud de los cultivos de maíz y mejora la resistencia de las plantas a enfermedades transmitidas por vectores.

Brasil y la cigarrinha do milho: nueva variante africana y el futuro de los bioinsecticidas
El país vecino confirmó la detección de la variante africana de chicharrita. El desarrollo de nuevos bioinsecticidas se presenta como una herramienta clave para combatir esta plaga. Un vistazo a los riesgos de la nueva variante y las estrategias de los productores brasileños, junto con las tendencias de registros en Brasil.
Por Matias Santipolo
Ingeniero agrónomo de la Universidad Nacional de la Plata U.N.L.P, con MBA en la Fundação
Getulio Vargas FGV. Actualmente director nacional de la empresa Gaia Agrosolutions (Brasil).

MANEJO DE PLAGAS
REVISTA AAPRESID 96
Ninfas y adultos en el interior del cartucho. Fuente: Revista Cultivar.

Actualmente, en Brasil se siembran alrededor de 22 millones de hectáreas de maíz. Los agricultores brasileños han convivido en los últimos años con Dalbulus maidis, comúnmente llamada “Cigarrinha do Milho” o “Chicharrita” en los países de habla hispana. La chicharrita y las enfermedades que causa están presentes en Brasil desde los años 70. Sin embargo, comenzaron a ser un problema mayor a partir de 2015, especialmente en las regiones del Sudeste, Centro-Oeste y Matopiba. En 2019, también se detectaron en el estado de Paraná, y desde entonces, el problema se ha extendido a otras partes del Sur y Centro-Oeste de Brasil.
Este insecto se convirtió en la principal plaga que tiene el cultivo del maíz y ha incrementado los costos de producción. Según la CEPEA, el aumento de costo fue superior a 50 USD/ha solo para intentar controlar este insecto. El potencial de daño puede llegar al 100%, dependiendo de la incidencia y la susceptibilidad del híbrido.

Reducción del tamaño de las espigas y problemas de polinización/granulación en plantas afectadas. Foto:
La chicharrita es responsable de la transmisión de los mollicutes (bacterias sin pared celular) spiroplasma y phytoplasma, así como del virus del rayado fino del maíz (Maize rayado fino virus). En las plantaciones de maíz, estos patógenos causan principalmente las siguientes enfermedades:
REVISTA AAPRESID 98
Felipe Souto.
Enfermedades en maíz
Achaparramiento pálido (Enfezamento pálido)
Achaparramiento rojizo (Enfezamento vermelho)
Rayado fino del maíz (Raiado fino)
Causas y síntomas
Causado por el procariota Spiroplasma kunkelii Whitcomb (Corn Stunt Spiroplasma).
Síntomas: hojas con estrías cloróticas, altura de la planta reducida, entrenudos acortados, brotes en las axilas de las hojas y un color rojizo en las hojas, con posibilidad de debilitamiento de los tallos y proliferación de espigas.
Causado por el procariota conocido con el nombre común de fitoplasma (fitoplasma del achaparramiento del maíz).
Síntomas: amarillamiento y/o enrojecimiento de las hojas, generalmente a partir de los bordes, ahijamiento y proliferación de espigas por planta.
Enfermedad causada por el virus del rayado fino del maíz.
Síntomas: formación de pequeñas manchas cloróticas en las hojas que pueden unirse a medida que avanza la enfermedad, formando líneas a lo largo de las venas (Sabato, 2013), con posibilidad de reducción del crecimiento y aborto de botones florales.
Imagen



Investigadores identifican una nueva especie de chicharrita del maíz
Investigadores de la Universidad Estatal de Ponta Grossa (UEPG) han identificado una nueva especie de chicharrita del maíz en el estado brasileño de Paraná. La chicharrita africana (Lepto Delphax maculigera), como se la denomina, se alimenta de cultivos de maíz y gramíneas, lo que puede causar daños en las cosechas.
Los primeros reportes de Lepto Delphax maculigera ocurrieron en 2023 en el estado de Goiás sobre maíz, pasto elefante (Cenchrus purpureus), brachiaria (Brachiaria decum-
bens) y también sobre plantas voluntarias de maíz en medio de plantaciones de poroto. Posteriormente, fue reportada en los estados de Paraná y Rio Grande do Sul, y luego en el resto de las regiones maiceras de Brasil (2023). Hasta entonces, la plaga no figuraba en los registros del MAPA. Esta nueva especie es originaria de África, con registros de ocurrencia en Costa de Marfil, Madagascar, Kenia y Camerún. Los estudios muestran que esta especie es un vector potencial de agentes fitopatógenos para los cultivos de maíz.

Adultos de Leptodelphax maculigera a)macho b) hembra. (Goiania 2022) Ferreira et al. (2023)
Gaia consultó a uno de los máximos referentes en la materia, quien comentó: “Es probable que la especie ya esté en todo Brasil”, advirtió el profesor Orcial Bortolotto, coordinador de la Granja Escuela Capão da Onça (Fescon-UEPG).
A través de análisis realizados a estos ejemplares se sabe que tienen la capacidad de portar
virus, espiroplasmas y fitoplasmas, pero poco se sabe de la capacidad de transmitirlos. “Todavía se necesitan más estudios para demostrar realmente la capacidad de este insecto para transmitir enfermedades”, señaló Bortolotto.
En resumen, Lepto Delphax maculigera está siendo una enorme preocupación en la comu-
REVISTA AAPRESID 100
nidad científica por su gran adaptación al clima de los estados del sur de Brasil. También preocupa la posibilidad de que sea polífaga, es decir, que se alimente de otras gramíneas, y principalmente la capacidad de ser un vector. Sin embargo, se sigue considerando potencial porque todavía no fue posible confirmar la trasmisión de enfermedades a campo ni tampoco a escala de laboratorio.
Impacto en el mercado de insumos
Los especialistas concuerdan en que no existe niveles de daño; la simple presencia de un insecto infectado produce daños en el cultivo. Por esto, es fundamental el monitoreo y la detección temprana.
En relación con moléculas tradicionales, ya desde hace un tiempo los productores vienen percibiendo que no llegan a niveles de control aceptables. Solo a modo de ejemplo, podemos ver en un ensayo realizado por la fundación Chapadão en Mato Grosso do Sul, donde ninguno de los químicos utilizados alcanza un 80% de control (Gráfico 1).
Por esta razón, las principales multinacionales han lanzado recientemente nuevos productos mejorando su formulación y mezclas de activos químicos.

Gráfico 1. Efecto de insecticidas sobre D.maidis en maíz. Porcentaje de control a 1 día después de la aplicación por diversos insecticidas con sus respectivas dosis en ingrediente activo por hectárea. Fundación Chapadão. Chapadão do Sul/MS - Cosecha 2015/2016. G.84. Fuente: Revista Cultivar.
Grandes problemas requieren grandes soluciones
En el actual escenario de alta presión de chicharritas, alto potencial de daño y baja eficiencia de los insecticidas convencionales, se aceleró la adopción de nuevas tecnologías que ayuden en el control. En este contexto, el uso de productos biológicos y fitoquímicos se ha convertido en una nueva estrategia. Actualmente es una estrategia complementaria, es decir, no sustituye el control químico, sino que actúa en conjunto, aumentando la eficiencia de los fitosanitarios tradicionales.
Los biológicos aportan el efecto “residual”, que no es como el de los químicos tradicionales. En el caso de los hongos entomopatógenos, estos
consiguen colonizar otros insectos y persistir en el ambiente por más tiempo. Los principales desarrolladores de biológicos del país insisten que esta “persistencia” es la principal ventaja de los biológicos vs. los químicos. Admilton Gonçalves de Oliveira Júnior, investigador de la Universidad Estadual de Londrina (UEL), comenta: “Los biológicos son la única herramienta de control que se multiplica en el ambiente, cooperando a favor del productor”.
Los agricultores latinoamericanos, debido a que no reciben subsidios por producir y, por el contrario, enfrentan una alta carga tributaria, son empresarios realmente ingeniosos, donde
REVISTA AAPRESID 102
las tecnologías que adoptan tienen que ser eficientes y ofrecer resultados. En este contexto, surgieron algunas de las más grandes soluciones para los grandes problemas de la agricultura. Un claro ejemplo de esto fue la incorporación de la siembra directa para la preservación del suelo frente a la erosión.
En este momento estamos frente a otra gran revolución liderada por los agricultores. Hoy Brasil se convirtió en el principal mercado de bioinsumos del mundo utilizados en agricultura extensiva. Actualmente, 223,6 millones de hectáreas fueron tratadas con biológicos entre todas las hectáreas cultivadas en la última campaña (Gráfico 2). Esto hizo que el sector en el país moviera 1,34 mil millones de USD en la comercialización de biológicos.

2. Área potencial tratada con productos biológicos. Campaña 22/23 vs. proyección estimada para la campaña 27/28.
Gráfico
La problemática de la Chicharrita del maíz potenció la adopción del uso de bioinsecticidas, haciendo crecer el mercado de bioinsecticidas
Visión de los registros y nuevos productos en Brasil
Para hablar sobre las tendencias de registro en Brasil, consultamos a Fabiana Cristina Bortolazzo Romano, ingeniera agrónoma de la Escuela Superior de Agricultura Luiz de Queiroz (Esalq/ USP), con maestría y doctorado en Entomología Agrícola, también por la Esalq, de la empresa SRI (Integrated Regulatory Solutions). Gaia Agrosolutions y SRI cooperan para ayudar a empresas de todo el mundo con el registro, desarrollo técnico y desarrollo comercial de Biodefensivos.

Gráfico 3. Número de registros obtenidos por empresas para control de chicharrita, Químicos vs. Biológicos + Fitoquímicos en el país. Según la consultora de mercado Blink, la adopción de bioinsecticidas en maíz llega al 25% del área.
La Dr. Romana señaló que en la actualidad hay más de 140 productos registrados para el control de la chicharrita del maíz, de los cuales casi el 46% son moléculas químicas y el 54% son productos biológicos (microbiológicos + fitoquímicos). De estos, 71 productos son a base de microorganismos registrados (Gráfico 3).
REVISTA AAPRESID 104
Solo en los últimos cinco años (2019-2023) se han registrado 87 productos para el control de plagas, de los cuales 29 son productos químicos (la mayoría en mezclas) y 58 son biológicos, lo que muestra la tendencia creciente en el uso de productos de origen biológico.
Entre los microorganismos utilizados para el control de Dalbulus maidis destacan Beauveria bassiana, Isaria fumosorosea, Beauveria bassiana + Isaria javanica y Pseudomonas chlororaphis + Pseudomonas fluorescens. Entre los fitoquímicos se encuentran los aceites esenciales como el aceite de Neem.
Durante 2024 y 2025 se espera la aprobación de unos 45 productos para controlar Dalbulus maidis que están a la espera de ser analizados en el Ministerio de Agricultura, todos ellos microbiológicos.
Existe una clara visión estratégica en Brasil donde se pretende promover el uso de biológicos, y esto es independiente de los gobiernos de turno. A pesar de que la normativa vigente para el registro de productos fitosanitarios sigue siendo una de las más estrictas del mundo, se ha demostrado una reducción de costos de hasta un 40% para el registro de insecticidas biológicos o fitoquímicos. En cuanto a los plazos de registro, si se compara un producto químico con un producto microbiológico, un químico tarda unos cinco años en obtener el registro, mientras que un microbiológico lo obtiene en unos ocho o diez meses.
Comentarios finales
Como director de una empresa que tiene como misión llevar innovación a los agricultores y distribuidores, es muy apasionante trabajar en un mercado como el brasileño. El agricultor que produce en una agricultura tropical nos desafía constantemente y demanda tecnologías cada vez más resistentes al clima y más eficaces.
Refugios: el escudo del maíz Bt
La resistencia, fenómeno natural de adaptación, no puede evitarse, sólo retrasarse con prácticas de manejo. En los cultivos Bt, la siembra de refugio es clave: al proporcionar insectos susceptibles, ayuda a mantener a raya la cantidad de individuos resistentes, prolongando así la vida útil de la tecnología.
Proteínas Bt
Las proteínas Bt son producidas por la bacteria del suelo Bacillus thuringiensis, de ahí su nombre. Son altamente específicas para algunos insectos, como los lepidópteros, y se activan al ser ingeridas, transformándose en toxinas que causan la muerte a dichos insectos.
Desde hace mucho tiempo, las proteínas Bt se han empleado para controlar las orugas en cultivos, generalmente formuladas como granula-
dos con cristales bacterianos. Desde finales de los años 90, contamos con maíces Bt, es decir, maíces genéticamente modificados a los que se les incorpora una o más proteínas Bt para el control de barrenador (Diatraea saccharalis), cogollero (Spodoptera frugiperda) e isoca de la espiga (Helicoverpa zea).
Como pasa con cualquier técnica de control, al estar siempre presente la proteína insecticida en el cultivo, se puede generar resistencia en los insectos blanco y para retrasarla necesitamos aplicar una serie de estrategias de manejo, entre las cuales la siembra de refugio es crucial.
Por: Fabiana Malacarne
Responsable programa Manejo de Resistencia de Insectos de ASA
MANEJO DE PLAGAS
REVISTA AAPRESID 106

Estrategia de refugios para combatir la resistencia
Las mariposas -o lepidópteros en términos científicos-, se reproducen por huevos que luego se transforman en larvas, las cuales causan daño en el maíz al consumir hasta el 80% de su peso. Luego, estas larvas pasan por una fase de pupa para finalmente convertirse en mariposas adultas. Después de aparearse, las mariposas vuelven a poner huevos para que su descendencia siga haciendo historia (o no) en tu lote.
Dado que la resistencia a las proteínas Bt es genéticamente recesiva, se requiere una estrategia específica para mantener baja la población de mariposas resistentes que podrían generarse en los cultivos de maíz Bt. Esto implica sembrar, en la misma fecha que el maíz Bt, un refugio con maíz no Bt de ciclo similar que represente al menos el 10% del área total.
En el refugio, al no haber proteínas Bt, pueden sobrevivir las mariposas susceptibles y, al aparearse con las resistentes provenientes del maíz Bt, darán descendencia susceptible que puede ser controlada por la tecnología.
Es fundamental que el refugio tenga un ciclo similar al del maíz Bt, se siembre en la misma fecha y a no más de 1.500 metros de la planta Bt más lejana. Esto asegura que las mariposas del Bt y del refugio nazcan al mismo tiempo, y así asegurar su apareamiento y producción de descendencia susceptible, que es lo que nos interesa. La distancia también es importante ya que se ha determinado científicamente que las mariposas plaga, especialmente el barrenador del tallo, pueden volar hasta 1500 metros para aparearse.
Repasando la genética del bachillerato:
La mariposa recesiva resistente (rr) provenien-

REVISTA AAPRESID 108
Más allá del refugio
El refugio sólo no es suficiente para mantener a raya la resistencia. Esta práctica debe complementarse con otras estrategias, como:
Rotación de cultivos para cortar el ciclo de las plagas.
Elección correcta de la tecnología Bt según fecha de siembra y plaga principal.
Buen control de malezas y tratamiento del rastrojo para evitar una elevada población inicial de insectos.
Buena implantación.
Monitoreo periódico de plagas tanto en la porción Bt del lote como en el refugio.
Control de la plaga cuando se alcancen los umbrales de daño recomendados.
Se viene la campaña 24/25 de maíz y seguramente ya elegiste el híbrido que mejor se adapta a tu zona. Si es Bt, no te olvides de comprar y sembrar el refugio para que cuando llegue la plaga, la tecnología de control siga siendo efectiva.
Si querés más información, ingresá a: www.programamri.ar.
Bananas argentinas: una fruta tropical con sello nacional
La producción de bananas en Argentina, aunque no tan conocida como en otros países, ha venido creciendo en los últimos años. Las principales zonas productoras se encuentran en el norte argentino. El caso de una empresa salteña que busca posicionar la banana argentina como una alternativa de calidad.
Por: Ing. Agr.
Antonella Fiore
Prospectiva - Aapresid
Plantas de bananos protegidos con ‘cuello de monja’ para un crecimiento perfecto en el norte argentino. Gentileza: Salvita Alimentos (https://www.salvitaalimentos.com/)


PRODUCCIONES ALTERNATIVAS
REVISTA AAPRESID 110
Las principales zonas productoras se encuentran en las provincias de Formosa (50,5%), Salta (47,7%) y Jujuy (1,8%). En Salta y Jujuy, existen fincas bananeras de superficies considerables (desde 7 hasta 380 hectáreas, con una superficie promedio de 68 hectáreas), con capacidad para incorporar tecnología y un sólido gerenciamiento. El caso de Formosa es diferente: su producción no puede competir en calidad con la banana salteña y la ecuatoriana, por lo que se comercializa localmente en las provincias del Noreste y Centro del país, y el porcentaje que llega a Buenos Aires y provincias del sur del país es casi nulo.
Las principales variedades comerciales de banana en Argentina pertenecen al género Musa, grupo Cavendish, dentro del cual se encuentra la variedad Nanica, la única que se ha difundido en la zona subtropical del país por su adaptación a las condiciones del medio.


REVISTA AAPRESID 112
Bananas salteñas, pioneras argentinas en cantidad y calidad
Los hijuelos o plantines de banana se implantan en el terreno donde se van a cultivar. Luego de su implantación, el banano o planta de banana alcanza una altura considerable entre los 10 y 11 meses, llegando a medir entre 3 y 4 metros en sus estados más avanzados. Aunque la producción de banana generalmente se lleva a cabo en climas tropicales a subtropicales, las variedades utilizadas en Argentina pueden adaptarse a temperaturas mínimas de 12 a 14 °C y máximas de hasta 35 °C.
La empresa Hijos de Salvador Muñoz (HSM) se dedica a la producción agrícola, incluyendo granos y hortalizas, y lleva a cabo la elaboración y procesos industriales de alimentos, que comercializa bajo la marca Salvita, que es el diminutivo del nombre Salvador. Además de su actividad principal, HSM ha diversificado con ganadería y ahora también con la producción de bananas.


En 2018, la empresa decidió retomar la producción de bananas después de casi tres décadas sin dedicarse a la actividad. HSM produjo esta fruta en los años 80, pero a principios de los 90, la convertibilidad y la facilidad de importación de productos extranjeros hicieron que el negocio dejara de ser rentable.
Actualmente, las fincas de HSM están ubicadas al norte de Salta, principalmente en Orán y Colonia Santa Rosa, con 600 hectáreas de plantaciones de banana. En una entrevista publicada recientemente, Salvador Muñoz, CEO de HSM, afirmó: “Estamos empezando a comercializar en el mercado nacional con muy buenos resultados. El mercado es muy grande y muy exigente en calidad. Trabajamos bien en Córdoba, Rosario, Tucumán, Salta y Jujuy. Y ahora llegamos a Buenos Aires, donde nos asociamos para trabajar con Tropical Argentina, una empresa que por su capacidad de proceso y distribución puede manejar el abastecimiento de toda la zona de Capital Federal y el Gran Buenos Aires”.
¿Cómo se alcanza esta calidad? Muñoz explicó que las plantaciones de Salvita fueron elaboradas mediante la reproducción de plantines en laboratorios, donde se producen meristemas de un clon elegido para tener plantas iguales y libres de patógenos. Además, se realizó una alta inversión en el sistema de riego (en este caso de fertirriego, ya que se añaden fertilizantes), que funciona diariamente para mantener los altos niveles de humedad requeridos por el banano.
Normalmente, la banana nacional en el norte de nuestro país corresponde a la variedad Nanica, de menor tamaño pero con gran cantidad de azúcar. Sin embargo, Salvita ha logrado trabajar exitosamente con la variedad William Cavendish, típica en la producción de países tropicales y asociada a primeras calidades por
su mayor calibre. La única diferencia que no se puede salvar es que el rendimiento de este fruto está condicionado por el factor climático. Y mientras Ecuador tiene un clima estable todo el año, el invierno en el norte argentino puede alcanzar, eventualmente, temperaturas bajo cero.
Otros aspectos importantes relacionados con el cuidado de la fruta durante su crecimiento incluyen varias técnicas y herramientas específicas. Por ejemplo, se utilizan plásticos conocidos como “cuello de monja”, que se colocan entre los racimos para separar la fruta y evitar que se golpee. Además, cada racimo se cubre con una bolsa para evitar el contacto con pájaros e insectos, lo que resulta en una fruta mucho más limpia. A estos cuidados se suma la instalación del cable vía, un sistema que facilita el transporte y manipulación de la fruta. El cable guía agiliza la recolección y transporte de los plátanos. Gentileza: Salvita Alimentos (https://www.salvitaalimentos.com/)


REVISTA AAPRESID 114
(https://www.salvitaalimentos.com/)

“Son tareas que van acompañadas de capacitación al personal, ya que es una forma distinta de trabajar el bananal respecto a la experiencia de los trabajadores que provienen de otras fincas de banano”, añadió Muñoz. Sin calcular el valor de la tierra, el productor estima que cada hectárea de banano representa una inversión de 25.000 dólares.
Para Salvita, esta es una apuesta fuerte, de largo plazo, que irá literalmente dando sus frutos con el correr de los meses. “Nos gusta invertir, probar cosas nuevas, confiamos mucho en lo que hacemos y pensamos que si se invierte se pueden lograr grandes resultados”, dijo Muñoz, quien puede dar cuenta de ello con los números de su empresa: más de 200 hectáreas de producción de hortalizas en invernadero y 25.000 hectáreas de producción de poroto, entre otras actividades.
 Gentileza: Salvita Alimentos
Gentileza: Salvita Alimentos
ALERTA frente al posible ingreso de plagas
La producción de banana en Argentina se localiza principalmente en el NOA y se encuentra libre de enfermedades graves como la Mycosphaerella fijiensis (conocida como “Sigatoka negra”), la Pseudomonas solanacearum, y la Stachylidium theobromae, todas cuarentenarias para el país. Por esta razón, el ingreso de fruta y material de propagación desde países limítrofes está regulado por normativas que protegen el estatus fitosanitario de la región.
La adopción de estas medidas implica la implementación de barreras cuarentenarias internas, lo cual facilita también el comercio en el país y evita la competencia desleal.
La Resolución ex SAGyP 99/94 prohíbe el ingreso al NOA de bananas (Musa spp.) que no cumplan con los requisitos fitosanitarios específicos, afectando, por ejemplo, la entrada del producto desde Bolivia. De igual forma, la Resolución SENASA 520/2005, posteriormente ratificada por la Resolución ex SAGPyA 823/2006,



REVISTA AAPRESID 116
Gentileza: Salvita Alimentos (https://www.salvitaalimentos.com/)
REFERENCIAS

extendió esta exigencia a las provincias de Formosa y Misiones, ya que los volúmenes que ingresan a través de su frontera provienen de Paraguay y Brasil, países donde se encuentran plagas de gran importancia que están ausentes en Argentina.
La “Sigatoka negra”, que desde 1960 afecta los cultivos bananeros en gran parte del mundo, provoca pérdidas significativas en la producción. Esta plaga ataca las hojas, que se secan e impiden la producción de frutos; la productividad de las plantaciones desciende verticalmente y los productores deben utilizar elevadas dosis de fungicida para mantener la actividad, lo que genera costos considerablemente altos. Argentina es uno de los pocos países libres de este hongo, por lo que impedir su llegada resulta esencial.
El ingreso de fruta y material de propagación desde países limítrofes está regulado por normativas que protegen el estatus fitosanitario de la región

Consulte las referencias ingresando a www.aapresid.org.ar/blog/revista-aapresid-n-230
El socio Aapresid que lleva 38 años sembrando futuro con raíces
Pionero de la siembra directa y socio Aapresid de la primera hora, Cristian Kleine lleva casi cuatro décadas demostrando que la clave está en cuidar las bases: las raíces y el suelo. Un panfleto sobre “sembrar sin tocar nada” lo llevó a unirse a la revolución de la SD y a cofundar la Regional Bahía Blanca hace 25 años.
Así como hay hinchas fervientes de equipos deportivos o seguidores de bandas musicales, Cristian es un defensor nato de las raíces y todo lo relacionado con el suelo. Su remera favorita podría fácilmente llevar la inscripción “Yo las raíces” en lugar del icónico “I New York”. De hecho, su foto de perfil en WhatsApp muestra un puñado de raíces junto con la fórmula (Rz + Mo) ® .
“Algunos me dicen que soy un fanático, pero la verdad es que no es fanatismo. Estoy convencido de que, tratando de imitar a la naturaleza, las raíces juegan un rol preponderante y son la solución al problema”, dice.
Su conexión con el agro viene de familia. Sus abuelos y sus padres eran de Prusia y en 1950 emigraron a Argentina, con la intención de seguir trabajando en el campo, como lo venían haciendo. Al poco tiempo de llegar al país, nace Cristian en Buenos Aires y cuando tenía tan solo 2 días de vida, su abuelo decide comprar un campo en el Delta Entrerriano, lindero con Uruguay. “Me crié ahí, siempre en contacto con el campo y también con el agua”.
Cuando llegó el momento de elegir una carrera, no tuvo dudas de que lo suyo era Agronomía y se instaló en Buenos Aires para estudiar en la UBA. Con título en mano, comenzó a dar sus pri-
SD - SOCIO DESTACADO
REVISTA AAPRESID 118


Ficha personal
Nombre: Cristian Kleine
Profesión: Ing. Agrónomo
Lugar de nacimiento: Nació en Buenos Aires, se crió en el Delta Entrerriano, y desde hace 38 años vive en Tornquist (Bs. As.), donde administró el campo de la Fundación Hogar Funke hasta 2018.
Familia: Casado, padre de 7 hijos y abuelo de ¡17 nietos!
Hobbies: “Me apasiona salir a pescar en canoa. Siempre que tengo oportunidad, voy a Entre Ríos o a los ríos del norte”.
meros pasos como ingeniero en varios campos de las sierras bonaerenses. Hasta que en el año 1985, lo llamaron para administrar la Fundación Hogar Funke, una entidad de bien público que recibe huéspedes de habla alemana y cuyo único capital es el suelo, debiendo financiarse a través de su propia producción agrícola-ganadera. Y allí es donde continúa actualmente.
“El panfleto del loco que quería sembrar sin tocar nada”
Cristian recuerda con lujo de detalles aquella exposición a la que habían ido con Ricardo Ochoa -uno de los fundadores de Aapresid-, en la que estaba Víctor Trucco repartiendo panfletos y presentándose como “el loco que quería sembrar sin tocar nada”.
A partir de este primer contacto, organizaron un pequeño congreso en Bahía Blanca y lo trajeron a Víctor para que diera una pequeña charla sobre su “idea loca”. “Gracias al entusiasmo contagioso de Víctor y a la oportunidad que tuvimos de visitar Estados Unidos en el 84, vimos que la solución podía pasar por ahí y fuimos varios los locos que nos sumamos a la movida de sembrar sin mover la tierra”, recuerda Cristian.
Así, empezaron los ensayos en el 85 con 8 hectáreas de Siembra Directa en la Fundación. “La locura salió bien, porque a los 5 años ya teníamos todo el campo en SD, luego de un fuerte trabajo de adaptación de las maquinarias a esta técnica”, cuenta orgulloso.
“Esa diversidad de suelos era nuestra mayor fortaleza. Juntarnos, compartir experiencias y novedades todos los meses, nos permitió crecer a todos”.
El ensayo original (que compara SD vs. Labranza convencional en 7 hectáreas para cada planteo a la par) lleva 38 años demostrando las bondades de la SD, lo que le mereció el nombre de “Monumento Histórico”. El mismo tiene un seguimiento constante por parte del investigador Juan Galantini, de la Universidad del Sur, y también se sumó Luis Wall, de la Universidad Nacional de Quilmes, para hacer un seguimiento de los microorganismos del suelo.
Gracias a este ensayo, se lograron aportar datos sumamente valiosos y Cristian no oculta su emoción al compartirlos: “Juan Galantini demostró que en convencional se pierden 11.500 kilos de tierra por hectárea y por año, algo que nos volvió locos. También, después de la seca de 2008/2009, evaluamos la cantidad de agua útil hasta 2 metros de profundidad, y el lote de SD tenía el equivalente a 160/180 mm de agua, mientras que el convencional tenía 25/55 mm, dos años seguidos”.
REVISTA AAPRESID 120
Cristian se entusiasma y suma otros datos: “Luis Wall hizo el seguimiento de los microorganismos del suelo y las buenas prácticas agrícolas, y demostró que el lote en SD era el que más micro y macro fauna tenía. Hace 10 años, cuando el ensayo tenía 27 años, Luis nos propuso invertir una parte de cada lote, pasando de SD a convencional y a la inversa, como una forma de evaluar la cantidad de micro y macro fauna que se va generando en el nuevo lote en SD y que se va a perdiendo en el ahora devenido convencional.” El ensayo sigue en pie y la idea es sumar nuevos académicos para que estudien el caso.



Cada región con su “librito de recetas”
Además de ser socio Aapresid de la primera hora (1987), Cristian es parte de una de las primeras Regionales Aapresid. “Ricardo Ochoa fue nuestro secretario en la Regional. Había armado un equipo junto con otros dos muchachos y compraron una máquina Baldán, con la condición de que tenían que hacer tres años el ensayo de SD en el mismo lugar. Fue después de esa experiencia que decidimos juntarnos un grupo de productores de la zona, que teníamos los mismos problemas de pendiente, de tosca cerca y otras yerbas, y creamos la Regional Bahía Blanca-Santa Rosa. ¡Esto fue hace 25 años!”.
Esta Regional fue una de las primeras en la zona, y abarcaba desde Bahía Blanca hasta Santa Rosa, con suelos totalmente distintos.
“Esa diversidad de suelos era nuestra mayor fortaleza. Juntarnos, compartir experiencias y novedades todos los meses, nos permitió crecer a todos”.
Con el diario del lunes, Cristian reconoce que el error que cometieron al principio fue querer importar recetas del “norte” -en referencia a Marcos Juárez, Rosario y otras localidades de la zona donde se dieron las primeras experiencias en Siembra Directa. “Con el tiempo, nos dimos cuenta de que teníamos que hacer nuestra propia experiencia; y en este camino nos sirvió el ensayo del monumento histórico, para se-
REVISTA AAPRESID 122
guir indagando y ajustando cosas de acuerdo al ambiente y a los desafíos que tenemos acá”.
Uno de los mayores desafíos que enfrenta esta región es la gestión del agua. “Las lluvias se concentran en otoño y primavera, y debemos cuidar esa agua en profundidad, además de no mover el suelo”, remarca.
Entre los muchos aprendizajes, recuerda uno en particular, que les dejó un contrato para hacer girasol confitero en la campaña 2004/05. “Nos dijeron que teníamos que sembrarlo con 25 mil plantas, cuando nosotros estábamos acostumbrados a 60 mil plantas. Al final, quedaron 13 mil plantas y sacamos 2000 kilos de girasol confitero. Esta experiencia nos permitió ver que, con menos densidad, el girasol pasó de rendir 1500 kg/ha a 1800 kilos/ha”.
Lo mismo pasó con el maíz. “Estábamos sembrando maíz en alta densidad y, si fallaba, se lo dábamos a la hacienda. Ahora sembrando 27.000 plantas, o sea, 2 o 3 veces menos de lo que veníamos sembrando, logramos una estabilidad que pasó de 1500 kilos a 4000 kilos de promedio en los últimos 10 años”, cuenta.
Actualmente, esta zona pasó a ser prácticamente una zona de cosecha gruesa, mucho más segura que la cosecha fina. “Tardamos 4 o 5 años en darnos cuenta de que había que bajar la densidad, y fuimos bajando cada vez más”.
Pero no solo capitalizaron aprendizajes en agricultura, sino también en ganadería. “Cuándo fue la sequía del 2008/2009, tuvimos una época de silos vacíos y lo único que nos salvó fue la vaca de cría. Tuvimos que vender 350 vien-
tres con el ternero adentro para pagar sueldos. Ahí nos dimos cuenta de que también teníamos que bajar la cantidad de vientres durante el año, para no estar pendientes de comprar suplementos en años difíciles. De esta forma, estabilizamos la preñez y le dimos estabilidad a la ganadería, básicamente porque el suplemento es el que impacta mucho los costos”.

Aapresid y su compromiso con el cuidado del suelo
Los más de 38 años como socio Aapresid consolidan la visión de Cristian sobre el rol fundamental de la institución en el cuidado del suelo. “El suelo es la base de todo”, afirma. “Antes, nos enfocábamos en la cobertura y en no removerlo, pero ahora entendemos que los verdaderos protagonistas son el suelo, las raíces y todo el mundo de microorganismos que los habitan”. Cristian también destaca la importancia de promover una Ley de Suelos a nivel nacional para garantizar la salud del suelo y su manejo sostenible.
Para entender el suelo, hay que meter mano. Por eso dice que la pala es la herramienta más importante en el campo. “Nos permite ver qué pasa en los primeros 30 cm del suelo y, en nuestro caso, realizar un seguimiento hasta 2 metros de profundidad para saber cuánta agua podemos almacenar. Esta información es clave para garantizar su cuidado”.
“Si tuviera que elegir dos palabras para hablar de Aapresid, serían conocimiento y amistad. Estos valores son pilares fundamentales del trabajo colaborativo que impulsa la institución en su búsqueda de una agricultura más sostenible”


REVISTA AAPRESID 124

En este camino, señala Cristian, Aapresid se destaca como un referente en la generación y difusión de conocimiento. “Si tuviera que elegir dos palabras para hablar de Aapresid, serían conocimiento y amistad. Estos valores son pilares fundamentales del trabajo colaborativo que impulsa la institución en su búsqueda de una agricultura más sostenible”, cierra.


6 principios básicos de la ganadería regenerativa GANADERÍA

No existe una receta única para la ganadería regenerativa, sino un conjunto de principios flexibles que se adaptan a cada realidad. En esta nota, nos metemos en el corazón de esta alternativa sostenible que revoluciona la forma en que manejamos la producción ganadera.

Por: Dr. Ing. Agr. José
Martín Jáuregui
Profesor Adjunto- Cátedra Forrajes (FCA - UNL).
En los últimos años, el término "regenerativo" ha ganado popularidad para describir prácticas productivas que buscan recuperar y mejorar características clave del medioambiente. Si bien no existe un consenso científico generalizado que defina el concepto de "regenerativo", hay principios importantes que son comunes entre quienes han acuñado este término. Inicialmente asociado con prácticas agrícolas, recientemente se ha introducido en la ganadería para describir sistemas que son "amigables" tanto con el ambiente como con las comunidades rurales. Pero, ¿qué significa la ganadería regenerativa? ¿Cuáles son los principios básicos y consensos que la rigen?
REVISTA AAPRESID 126

No hay recetas ni nombres propios, sólo principios adaptables
Como se mencionó, no existe una receta específica para la regeneración. Tampoco hay nombres propios o sistemas de manejo únicos que puedan atribuirse ser "dueños" de la regeneración. En cambio, la mayoría de los estudios coinciden en que la ganadería regenerativa se basa en un conjunto de principios adaptables a los contextos locales. A continuación se describen algunos de ellos.
Novillos en pastoreo en campos naturales del estado de Santa Catarina (Brasil).
1
Los productores ganaderos que apuntan a realizar prácticas de regeneración exitosas conocen su contexto individual: su clima, geografía, recursos, habilidades, dinámicas familiares, objetivos y cualquier otro factor que influya en ellos y su operación. Comprenden cómo funcionan los procesos ecosistémicos en su tierra, lo que les permite trabajar con esos procesos.
Por ejemplo, un productor de una región semiárida tendrá que adaptar sus prácticas regenerativas a la escasez de agua, seleccionando especies forrajeras tolerantes a la sequía y ajustando su manejo del pastoreo en consecuencia. Por otro lado, uno que se ubique en una zona más húmeda y fértil podrá enfocarse más en aumentar la diversidad de especies y promover una mayor actividad biológica en el suelo.
2
La salud del suelo
La salud del suelo es un concepto central. A diferencia de la fertilidad, que se centra en niveles de nutrientes, el concepto de salud abarca características más amplias como ciclos naturales, biodiversidad y capacidad para proveer servicios ecosistémicos. En la ganadería regenerativa, se busca maximizar los servicios ecosistémicos y la recirculación de nutrientes,
Las dinámicas familiares y la mano de obra disponible son otros factores importantes a considerar. Algunas prácticas regenerativas, como el pastoreo rotativo intensivo, pueden requerir más mano de obra que los sistemas continuos, lo que puede no ser factible en campos más pequeños o con recursos limitados. En resumen, conocer a fondo el contexto específico y adaptar las prácticas regenerativas en consecuencia es clave para el éxito a largo plazo.
Conocer a fondo el contexto específico y adaptar las prácticas regenerativas en consecuencia es clave para el éxito a largo plazo.
a la vez que se evitan los procesos que perturban la estructura del suelo. Prácticas como la siembra directa de pasturas y verdeos y el pastoreo rotativo adaptativo (en el que los animales se mueven con frecuencia entre pequeños potreros), ayudan a evitar la compactación y mejoran la estructura y retención de agua del suelo, entre otros factores positivos.
que
Conocer el contexto y el entorno
rodea al productor
REVISTA AAPRESID 128

A la izquierda se observa un suelo sometido a agricultura continua. A la derecha un suelo bajo pasturas. La foto corresponde a sitios adyacentes de las Great Plains de Estados Unidos. El color más claro denota un menor contenido de materia orgánica. Asimismo, se observan sectores compactados en el suelo de la izquierda.
Mantener el suelo cubierto durante la mayor parte del año es otra de las prácticas consideradas centrales en la ganadería regenerativa. Esto se logra evitando el sobrepastoreo y permitiendo que el pasto tenga periodos de descanso adecuados, que se ajusten a sus requerimientos ecofisiológicos. El pastoreo intensivo de corta duración, por ejemplo, bus-
ca que los animales pastoreen en áreas pequeñas por poco tiempo, tratando de emular el comportamiento gregario evolutivo del rumiante y permitiendo que el pasto se recupere y mantenga una cobertura vegetal adecuada. Esta cobertura protege el suelo, mejora la infiltración de agua y proporciona hábitat para la biodiversidad edáfica.
Promoción de la biodiversidad y fijación de carbono
La ganadería regenerativa promueve la biodiversidad de especies vegetales y animales. Las pasturas y pastizales mixtos que incluyen varias especies forrajeras pueden mejorar la salud del suelo y proveer dietas más equilibradas al ganado. Asimismo, especies diversas son capaces de soportar mejor los vaivenes climáticos, otorgándole mayor resiliencia al sistema. Esto también puede emularse parcialmente sembrando distintas especies puras en diversos ambientes del campo, buscando así optimizar la producción de cada uno de estos ambientes. Además, pastorear utilizando especies diversas como bovinos, ovinos, ca-
prinos, equinos e incluso aves puede generar un impacto positivo en el sistema al reducir la selectividad y mejorar el aprovechamiento del recurso. El pastoreo poliespecífico, sin embargo, debe ser utilizado estratégicamente ya que puede incrementar la compactación del suelo y el sobrepastoreo.
Asimismo, las prácticas regenerativas buscan incrementar el input de carbono al sistema, generalmente mediante el incremento de la producción de raíces y la exploración de horizontes más profundos del suelo.
de la
Mantenimiento
cobertura del suelo
3
4
REVISTA AAPRESID 130

y ovejas en pastoreo en campos ganaderos.
Integración de ganado y cultivos 5
Durante mucho tiempo, los rumiantes han sido una parte integral del ciclo natural en los campos. El concepto de campo “agrícola” o “ganadero” es relativamente moderno, y durante décadas la agricultura convivió con la ganadería. Esto significó que los lotes se rotaran con pasturas cada cierto número de años. En este sentido, la ganadería regenerativa también persigue la integración de animales en sistemas agrícolas. Los rumiantes, en particular, son valorados por su capacidad para recircular nu-
trientes del suelo a partir del estiércol, lo que aumenta la presencia de insectos y microorganismos beneficiosos, mejorando la productividad de los cultivos sucesivos y reduciendo la dependencia de fertilizantes sintéticos. Además, la presencia de ganado en los campos permite la inclusión de cultivos de servicio en la rotación agrícola, lo cual, bajo manejos de pastoreo moderado, permite incrementar la biomasa de raíces total generada (para más información ver nota publicada en la edición pasada).
Novillos
La siembra de verdeos y cultivos de servicio busca reducir la perturbación del suelo y mantener la cobertura vegetal durante todo el calendario agrícola. Todas estas intervenciones tienen como objetivo minimizar la erosión y aumentar la profundidad, estructura y contenido orgánico del suelo, mejorando así su fertilidad.
Si bien las prácticas mencionadas son comunes, la ganadería regenerativa también se define por sus resultados deseados: mejorar la salud del ecosistema, aumentar la biodiversidad, mejorar la capacidad del suelo para retener
El rol de la ciencia y la evidencia empírica
La ganadería regenerativa se basa en un enfoque interdisciplinario que combina aportes de diversas áreas científicas como la ecología, la biología, la química, la física y la producción animal, entre otras. Si bien reconoce la importancia del conocimiento tradicional y las prácticas ancestrales de manejo de la tierra, la ganadería regenerativa busca evaluar sus impactos mediante un riguroso análisis científico y la recopilación de evidencia empírica sólida.
Esto implica la necesidad de realizar investigaciones a largo plazo y a gran escala, utilizando métodos científicos robustos para medir y cuantificar los efectos de las prácticas regenerativas en diferentes contextos ambientales, climáticos y socioeconómicos. Además, se promueve un
agua y nutrientes, y reducir las emisiones de gases de efecto invernadero. Los productores ganaderos tienen libertad para experimentar y adaptar prácticas específicas según sus contextos locales a fin de lograr estos resultados.
proceso continuo de revisión y adaptación basado en los hallazgos obtenidos, con el objetivo de mejorar las prácticas y maximizar los beneficios tanto para el medioambiente como para las comunidades rurales.
Aunque existe un creciente cuerpo de investigación que respalda los beneficios de las prácticas regenerativas, aún hay incertidumbre y debate en torno a algunos de los impactos reclamados, especialmente en lo que respecta al secuestro de carbono en el suelo a largo plazo y en diferentes ecosistemas. Por ejemplo, algunos estudios sugieren que si bien los sistemas regenerativos pueden secuestrar carbono inicialmente, este efecto podría disminuir o revertirse con el tiempo debido a factores como la
6
Enfoque en los resultados
REVISTA AAPRESID 132
saturación del carbono en el suelo o cambios en la composición de la vegetación. Además, existe debate sobre la magnitud real de este secuestro y su potencial para compensar las emisiones de metano producidas por el ganado.
Por todo lo anterior, es importante destacar que, si bien la ganadería regenerativa ha ganado popularidad en los últimos años, aún existen brechas de conocimiento y áreas de incertidumbre que requieren una investigación más profunda. Por lo tanto, es fundamental
Conclusión
La ganadería regenerativa representa una evolución en cómo entendemos y manejamos la producción ganadera. Al centrarse en principios ecológicos y resultados deseados, más que en recetas específicas, ofrece un enfoque flexible y adaptativo que puede beneficiar tanto al medioambiente como a las comunidades rurales. Sin embargo, para alcanzar su potencial, es necesario un compromiso continuo con la investigación interdisciplinaria rigurosa, la recopilación de evidencia empírica sólida, la innovación y el intercambio abierto de conocimientos entre diferentes actores y disciplinas.
Solo a través de este proceso de aprendizaje colaborativo basado en la ciencia podremos desarrollar sistemas ganaderos verdaderamente regenerativos y sostenibles, abordando las bre-
mantener un enfoque crítico y basado en la evidencia, evitando afirmaciones dogmáticas y promoviendo el intercambio abierto de información entre diferentes actores y disciplinas.
La ganadería regenerativa busca evaluar sus impactos mediante un riguroso análisis científico y la recopilación de evidencia empírica sólida.
chas de conocimiento existentes y promoviendo la adopción de prácticas respaldadas por evidencia científica y adaptadas a las condiciones locales. Un enfoque crítico y abierto al escrutinio científico será fundamental para evaluar los impactos reales de la ganadería regenerativa y maximizar sus beneficios potenciales.
Al centrarse en principios ecológicos y resultados deseados, más que en recetas específicas, ofrece un enfoque flexible y adaptativo que puede beneficiar tanto al medioambiente como a las comunidades rurales.

REVISTA AAPRESID 134






















































































 Figura 1: Ensayo de evolución de dinámica poblacional de Pulgón amarillo en sorgo. Martín Galli - Campaña 2022-23
Figura 1: Ensayo de evolución de dinámica poblacional de Pulgón amarillo en sorgo. Martín Galli - Campaña 2022-23










































 Figura 6. Aspecto de las plantas y espigas de híbridos sensibles y tolerantes al achaparramiento del maíz transmitido por Dalbulus maidis.
Fecha de siembra del cultivo de maíz
Figura 7. Ensayo de maíz para evaluar el impacto de Dalbulus maidis en diferentes fechas de siembra del cultivo de maíz, campaña 2023/24. 1° FS: 26 de diciembre de 2023, 2°FS: 12 de enero de 2024 y 3°FS: 7 de febrero de 2024.
Figura 6. Aspecto de las plantas y espigas de híbridos sensibles y tolerantes al achaparramiento del maíz transmitido por Dalbulus maidis.
Fecha de siembra del cultivo de maíz
Figura 7. Ensayo de maíz para evaluar el impacto de Dalbulus maidis en diferentes fechas de siembra del cultivo de maíz, campaña 2023/24. 1° FS: 26 de diciembre de 2023, 2°FS: 12 de enero de 2024 y 3°FS: 7 de febrero de 2024.